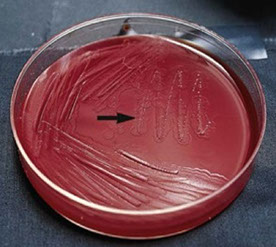
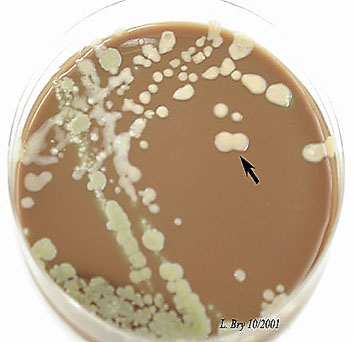
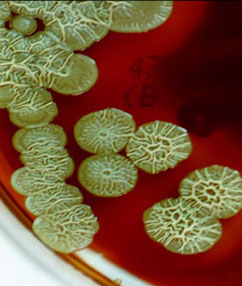
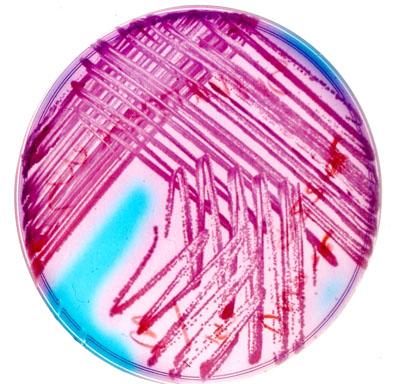
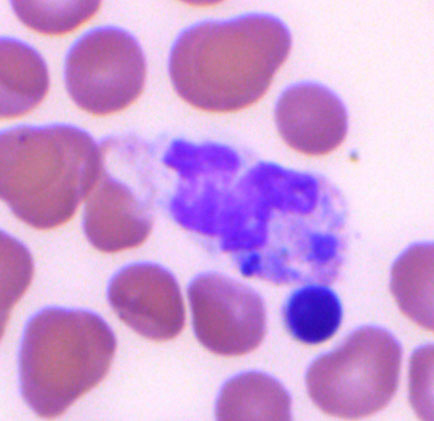

MICROBUGZ
http://www.austincc.edu/microbugz/index.php
Bacteriology
Acute phase cytokines = IL-1, IL-6, TNF-a
Definitions
Bacterial Anatomy
Growth phases
Specimen Collection Requirements
Culture Media
Stains
Specimen Adequacy Requirements
Bacterial resistance mechanisms
Bacterial virulence factors
Testing Methods
- General
- Quality Control (QC)
- Kirby Bauer disk diffusion
- E test
- Broth dilution / Minimum Inhibitory Concentration (MIC)
- B-lactamase detection
- Other general and special tests
Gram-negative glucose non-fermenters
- Fermentative and oxidative
- Non-fermentative gram-neg bacilli
-
Approaches to identification
- King-Weaver schema, Pickett Schema, Gilardi's approach, Commercial Kits and systems
Special testing on bugs
- Methicillin-resistant Staph aureus (MRSA)
- Vancomycin resistant enterococcus (VRE)
- Extended Spectrum B-Lactamase - Klebsiella pneumonia carbapenemases (ESBL/KPC)
- Strep pneumonia
- Amplified Gono/Chlamydia test
- Clostridium difficile
- Molecular testing
Micrococcaceae
- Staphylococcus aureus
- Staphylococcus epidermidis
- Staphylococcus saprophyticus
- Rothia mucilaginosa
- Micrococcus spp.
Enterococcus
Streptococcus pyogenes (Gp A Strep)
Streptococcus agalactiae (Gp B Strep)
Streptococcus pneumoniae
Viridans Streptococcus
Gram-(+) Bacilli: non-spore formers
- Corynebacterium spp.
- Corynebacterium diphtheriae
- Listeria monocytogenes
- Erysipelothrix
Gram-(+) Bacilli: Spore forming
- Bacillus anthracis
- Bacillus cereus
Misc. Aerobic Gram-(+) Bacilli
- Lactobacillus spp.
- Arcanobacterium haemolyticum
- Rothia dentocariosa
Gardnerella vaginalis
Anaerobes
-
Gram Negative
- Bacteroides Fragilis
- Bile-sensitive pigmented gram neg bacilli (prophyromonas and prevotella)Fusobacterium
- Varonella
-
Gram + bacilli
- Clostridium (perfringens, difficile, tetani, botulinum)
-
Gram + Non-spore forming Bacilli
- Actinomyces
- Bifidobacterium
- Propionibacterium
- Mobiluncus
-
Gram + Cocci
- Peptostreptococcus
- Peptococcus
Aerobic Actinomycetes
- Nocardia
- Streptomyces
- Actinomycetoma
- Rhodococcus equi
- Miscllaneous Actinomycetes (Oerskovia spp, Dermatophilus congolensis, Tropheryma whipplei)
Anaerobic actinomycetes
Actinomyces spp. (bovis, israelii)
Neisseriaceae
- Neisseria meningitidis
- Neisseria gonorrhoreae
- Moraxella catarrhalis
Chalmydia (trachomatis, pneumoniae, psittaci)
Haemophilus
- H influenzae
- H ducreyi
Pasteurella
Pseudomonas and related organisms
- Pseudomonas aeruginosa
- Pseudomonas fluorescens and Pseudomonas putida
- Burkholderia pseudomallei
- Stenotrophomonas maltophilia
- Stutzeri group Pseudomonas
- Shewanella putrefaciens
- Alcaligenes group pseudomonads
- Brevundimonas diminuta / vesicularis
- Sphinogmonas paucimobilis / parapaucimobilis
Enterobacteriae
- Escherichia coli
- Escherichia albertii
Citrobacter
Edwardsiella
Cedecea
Salmonella
Shigella
Cronobacter
Vibrio
Aeromonas
Chromobacterium
Yersinia enterocolitica
Yersinia pestis
Yersinia pseudotuberculosis
Klebsiella pneumoniae
Enterobacter
Serratia (marcescens / liquefaciens)
Morganella
Proteus (mirabilis / vulgaris)
Providencia
Campylobacter jejuni enteritis
Helicobacter pylori
Arcobacter
Spirochetes (***BLT**)
- Treponema pallidum
- T pallidum spp pertenue
- T carateum
- T pallidum spp endemium
- Borrelia (burgdorferi and more)
- Leptospira
- Spirillaceae
Brucella
Bordetella (pertussis / parapertussis)
Francisella tularensis
AfipiaBartonella
Streptobacillus moniliformis
Actiobacillus
Kingella
Capnocytophaga
Legionella pneumophila
Mycoplasma pneumonia and Ureaplasma
Cardiobacterium hominis
Somonsiella
Dermatophilus congolensis
Dysgonomonas
CDC GPS. EF-4a and EF4b
Misc Non-Fermenters
- Acinetobacter
- Chryseobacterium meningosepticum
- Empedobacter brevis
- Myroides spp
- Weeksella virosa
- Bergeyella zoohelcum
- Moraxella spp
- Eikenella corrodens
- Alcaligenes spp
Bioterrorism
- Anthrax,Brucellosis, Cholera, Glanders, The plague, Tularemia, Q-fever
- Venezuelan Equine Encephalitis
- Viral Hemmorrhagic fevers
Smallpox
Botulinum toxin
Staphylococcal Enterotoxin B
Ricin
T-2 Toxins
Acute Phase Cytokines (APC)
IL-1, IL-6, TNF-a
Classification
Gram (+) Cocci
Staphylococcus, Streptococcus
Gram (-) Coccus
Neisseria
Gram (+) Rods (bacilli)
Clostridium, Corynebacterium, Bacillus, Listeria, Mycobacterium (acid fast)
Gram (-) Rods (bacilli)
Enterics (E coli, Shig, Salm, Yersinia, Kleb, Proteus, Enterobacter, Serratia, Vibrio, Campylobacter, Helico, Pseudomonas, Bacteroides), Hemophilus, Legionella (silver stain), Bordetella, Francisella, Brucella, Pasteurella, Bartonella, Gardnerella
Gram (+) Branching filamentous
Actinomyces, Nocardia (weak acid fast)
Gram (-) Pleomorphic
Ricketsia, Chlamydia
Gram (-) Spirochetes ***BLT***
Borrelia (Giemsa), Leptospira, Treponema
No cell wall
Mycoplasma
Definitions
Obligate aerobe - needs oxygen to thrive
*** Nasty Pus Must Breath ***
Nocardia, Pseudomonas, Mycobacterium, Bacillus
Obligate anaerobe - thrives w/o O2; O2 is toxic; tx c metronidazole and clindamycin
*** Can't Breath Air
Clostridium Bacteroides Actinomyes***
Facultative anaerobes - most bacteria are this; may thrive c or w/o O2
Aerotolerant anaerobes - anaerobes that are not killed by O2 exposure (Clostridium terium)
Obligate intracellular bugs - cannot make ATP
*** Really Cold - Rickettsia and Chlamydia ***
Exotoxins - polypeptides made from plasmids that are secreted from gram neg and pos and are really toxic
- except for staph enterotoxin, get destroyed at 60 C
- ie tetanus, botulism and diphtheria
Endotoxins - lipopolysaccharides from bacterial outer membrane (gram neg and listeria) made from bacterial chromosome that is released if lysed and induces APCs and causes fever/shock but has low toxicity
- very heat stable, but poorly antigenic (can't make vaccines)
- ie meningococcemia and sepsis from gram neg rods
Bacterial Anatomy
Bacterial cell wall - major surface ag, made of peptidoglycan (murein layer, supportive sugar backbone, techoic acid induces APCs), N-acetylglucosamine (NAG), N-acetylmuramic acid (NAM)
- provide rigidity, osmotic membrane
- outer membrane seen in Gram negative while teichoic acid is in Gram (+)
Cyoplasmic membrane - outer membrane in gram-(-)phospholipid bilayer with mix of mostly proteins and lipids and responsible for generation of ATP
- also are major surface ag and have selective permeability, excrete enzymes
- endotoxins found here
- Lipid A causes release of APCs
Flagella - bacterial motor that made of >40 proteins in complex array
- can be monotrichous, lophotrichous, amphitrichous or peritrichous
- Enterobacteriaceae has "H" antigen
Pili - little hairs made of protein used to adhere to surfaces or for sex (conjugation)
Axial fibrils (filaments) - used for motility, has outer sheath
- seen in spirochetes
Capsule - polysacharide that protects from phagocytosis (except B acthracis has D-glutamate)
- cause positive quellung rxn (swells)
***quellung swellung***
- capsular bugs: Klebsiella, Salmonella, Strep pneumo, H influenza type B, Neisseria
***Kapsule Saves SHiN ***
- the "SHiN" bacteria also make IgA protease, can cause meningitis, and undergo transformation (take up DNA from envt) cause meningitis, transform DNA
Bacterial Ribosomes - 70s (50s + 30s) in prokaryotes vs eukaryotic ribosomes 80s (60s + 40s)
***80 evens euks and 70 odds proks***
- in the cytoplasm; made of >50 proteins, are molecular machines
Nuclear characteristics - has one big circular chromosome with no nuclear membrane
- plasmids are pieces of extrachromosomal DNA responsible for virulence and resistance factors
Metabolism - catabolic or anabolic, and is used to generate ATP and synthesize macromolecules
- substrate phosphorylation - seen c fermentation
- electron transport phosphorylation in oxidative phosphorylation (much better energy yield than substrate phosphorylation)
- synthesis of macromolecules can be template directed (for nucleic acids and proteins) or enzyme specific (polysaccharides and lipids)
Growth Phases
Exponential / Log phase - good for any testing
- usually at ~24 hrs on agar
Lag phase - growth curve starts to slow down
- not good for testing
- occurs after 24 hrs on agar plate
Stationary phase - optimal for specimen transportation
Decline phase
Specimen Collection Requirements
Anaerobes - eSwab or vial - obviously no O2
CSF - use a sterile container at room temp or incubate @ 35C for bacterial culture
N. gonorrhea - charcoal swab; DO NOT REFRIGERATE (bc charcoal protects from a harsh environment; generally you want to put in fridge if unable to plate immediately)
Swabs - Stuart's or Aimes transport (peptone buffers) preserve organisms but do not promote growth
Urine - use boric acid to keep in stationary phase or you can put in fridge for an hour
- should not be cultured >24 hrs
Culture Media
Selective media - abx added to select for particular organisms
- PhenylEthyl Alcohol (PEA) - selects for gram positive cocci
Differential media - chemical added to media to differentiate organisms based on color
Differential AND Selective media - ie MacConkey agar selects for gram negative bacilli and differentiates lactose fermenters
Blood agar - 5% sheep's blood agar
- allows growth of all bacteria except Hemophilus
- good for checking hemolysis
Blood-glucose-cysteine agar - promotes mold-to-yeast conversion of dimorphic fungi, such as H capsulatum, B dermatitidis, Paracoccidioides brasilienses and sporothrix schenkii
Chocolate agar - "cooked" blood agar (enriched)
- has hemin and NAD, which support fastidious orgs
MacConkey agar - gram negative bacilli (lactose fermenters), has bile salts and crystal violet dye, inhibiting gram pos
- Red/Pink = lactose fermenters
- Clear = not lactose fermenters
-- either way only gram negative bacilli grow
MTM: Modified Thayer Martin (Vancomycin, Colistin, Nystatin, Trimethoprim lactate
- VPN agar (Vancomycin [for gram (+), Polymyxin for gram (-), Nystatin for fungi)
*** in order to get into your VPN client, you must be Neisseria ***
Martin Lewis: (Vancomycin, Colistin, Trimethoprim lactate, Anisomycin)
New York City Medium: (Lysed horse blood, Vancomycin, Colistin, Trimethoprim, Amphoteracin B)
Mueller Hinton agar - used for antimicrobial suscept. in non-fastidious (easy to please, well-growing?) bugs
- grows lots of bugs, minimal abx inhibition, reproducible batch-tobatch
- the standard bacterial innoculum is 0.5 MacFarlands (approx 1-2 x 10^8 CFUs/mL) - adding more or less can affect results and lead to very dubious results
- if new abx panel available must run susceptibility testing every day for a month and be outside of normal range for 3 tests
Lowenstein-Jensen Medium
- Whole eggs, potato flour, glycerol, malachite green, No agar; takes up to a month
- Asparagine stimulates Niacin production
- Lowenstein-Jensen Gruft: same as above with added Penicillin, Nalidixic Acid, and RNA
Middlebrook 7H10 agar
- Clear medium, agar based
- Biotin, pyridoxine, malachite green, OADC enrichment (oleic acid, bovine albumin, fraction V, glucose, catalase)
Other Culture Media
- Middlebrook 7H11 selective agar
- Middlebrook 7H9 broth for surgical specimens & normally sterile fluids
- BBL MGIT (Mycobacteria Growth Indicator Tube)
- MGIT tubes are read daily for an orange-red fluorescence
Bordet-Gengou (potato) medium or Regan-Lowe (charcoal) medium
*** BORDET for BORDETella ****
Stains
Gram stain
Gram negative are red and Gram positive are blue
- depends on cell wall structure
- has Crystal violet (stains peptidoglycan cell wall), Gram's iodine (mordant), Acetone / EtOH (decolorizer), Safranin (counterstain, for gram neg visualization, last step)
- if neuts are blue the slide is under-decolorized
- if neuts are washed out, slide is over-decolorized
Ziehl-Neelson Stain
The classic Acid Fast stain; positive in mycobacterium
Periodic acid-Schiff (PAS)
Highlights Tropheryma whippelii (Whipple's dz); stains glycogen, mucopolysaccharides
***PASs the sugar ***
Silver stain
Fungi (such as Legionella and Pneumocystis)
Specimen Adequacy Requirements
Sputum
Specimen is not adequate if >25 epithelial cells / field on 10x (which is then judged to be spit and not sputum)
Bacterial Resistance Mechanisms
Enzymatic cleavage
- Developes B-lactamases (for B-lactam abx) and aminoglycoside modifying enzymes (for aminoglycoside abx
- Carbapenems (imipenem, meropenem) can be used for Extended-Spectrum B-Lactamase (ESBL) producing bugs (plasmid encoded = easy to transfer)
-- MCCs of ESBL-producing bacteria are Klebsiella pneumoniae and E coli
- pts c ESBL-producing bugs must be put in isolation to avoid P2P transmission
Altered receptors / binding proteins that inhibit abx from binding bacterial surface
- altered Penicillin binding proteins; S pneumonia resistant to penicillin and MRSA resistance to methicillin
Altered influx / efflux / permeability through porin (pumps) [seen in gram neg bacilli]
- Pseudomonas resistant to aminoglycosides
Going around metabolic block
- enterococcus resistant to TMP-SMX
Urease Positive Bugs
Proteus, Kleb, H pylori, Ureaplasma
*** Particular Kinds Have Urease ***
Bacterial Virulence Factors
Protein A - seen in S aureus; binds Fc of Ig, preventing opsonization and phaocytosis
IgA protease - SHiN bacteri, helps in colonization of the respiratory mucosa
M protein - gr A Strep; prevents phagocytosis
Testing Methods
General
Clinical Laboratory Standards Institute (CLSI) approves standards for testing and reporting susceptibility results (publishes yearly)
- such as appropriate abx to test and QC standards and proper procedures
- antimicrobial battery made by hospital infx control committee (CLSI publishes material on what tests to include)
Selective reporting - not including information that isnt clinically useful
These standards are based on acheivable blood levels by the abx
- abx levels used in UTIs may be ober-predicted
Also tests bacterial stasis
All methods must have:
- Culture of a single organism ONLY
- Log phase growth
- Standardized suspension of an organism
-- 0.5 McFarland Standard (barium sulfate standard that equals turbidity at 10^8 bacterial CFU / mL
-- can also use a spectrophotometer
- incubation at 35C in room air
- 18-24 hrs (species dependent)
Intrinsic resistance - resistance from normal genetic, structural or physiologic states of a bug
Acquired resistance - resistance from altered cell physiology and structures caused by changes in bugs usual genetic makeup; can also be a triat assoc c only some strains of a spp but not others
- resistance can be conferred by plasmids, transposons or B-lactamases
Quality Control (QC)
All tests must have 20 days of consecutive QC in CLSI established limits usuing American Type Culture Collection (ATCC) strains of bugs
- after this is passed, then a weekly QC is performed on all lots in use; the data is recorded and reviewed monthly
-- if QC does NOT pass (out of control)... must immediately repeat and inform supervisor (if repeat is good then continue testing; if repeat NOT good then must fix problem and repeat 5 times which are all good)
Kirby Bauer Agar Disk Diffusion Test
Good for rapidly growing bugs; using Mueller-Hinton agar (150mm plate diameter that is 4mm deep and uses balanced Ca2+ and Mg2+ [if ions are too high aminoglycosides appear falsely resistant and if too low look falsely susceptible]) you put the bacteria on the plate c a cotton swab
- place a 6 mm paper disk that has a single abx and incubate
- after incubation measure the diameter of growth inhibition in mm and report based on a chart that translates zone size as Sensitive/Susceptible, Intermediate or Resistant (sizes are specific per each abx)
-- can also be moderately susceptible in report
- agents used are selected by hospital infection control committee
Quality control done by using specific ATCC orgs (P aeruginosa, E coli, S aureus, enterococcus), and if any unexpected results, but considered test invalid
Note: do NOT read a mixed sensitivity (something about double zoning...)
E test
Similar to disk diffusion, put plastic strips c abx on agar surface and diffuse out in an ellipse
- MIC is where ellipse ends on the plastic strip
-- may be done qualititatively and read as mcg/mL as elliptical zone around plastic measuring tool
- good test for tough organisms that are slow-growing
Broth Dilution
0.5 McFarland standard that is then diluted to 5x10^5 orgs /mL
- this suspension is inoculated into test tubes or micro titer trays that have a growth medium and a known 2-fold dilution of abx
-- gotta have 4+ dilutions to be considered a true MIC
Minimum Inhibitory Concentration (MIC) =lowest [abx] that inhibits growth (bacteriostatic)
- determined by serial 2-fold dilutions of abx, can be done in conventional tubes or microtiter trays
- the MIC sometimes called a breakpoint, and so these are sometimes called breakpoint panels
- agar dilution is gold standard but broth dilution use is common
- usually report the both MIC and the interpretative category
90-60 rule - infections respond to tx in ~90% if the infx agent judged to be susceptible in vitro, while infx respond to tx about 60% of the time when infx agent judged to be resistent in vitro
- also applies to bacterial, fungal and parasitic infx
Min Bactericidal Conc (MBC) = lowest [abx] that kills 99.9% of original inoculum
- aka Minimum Lethal Concentration (MLC)
- Designated: Susceptible, Intermediate, or Resistant
-- Susceptible bugs tx'd c normal dosing
-- Resistant bugs not inhibited by the abx
Antibiotic tolerance = MBC / MIC that is >= 32
Serum Bactericidal Test (aka the Schlicter Test)- similar to MIC/MBC except that uses pts own serum with the abx already in there
- the lowest dilution of pts serum that kills a standard inoculum of a bug called the serum bactericidal level
-- serum bactericidal level >1:8 is effective therapy
B-lactamase detection
Bacteria is added to filter paper with chromogenic cephalosporin (Nitrocefin) and then incubated (up to an hour, depending on the bacteria)
- aka Cefinase disk test
- Yellow to pink / red, STOP bc the test is positive, 2/2 bacteria with B-lactamase enzyme breaking down a B-lactam ring and forming a red end product
- detects resistance to Ampicillin, Penicillin and cephalosporin in N gono, M catarrhalis, Haemophilus influenza (up to 40%, Ampicillin resistant), B fragilis (Penicillin resistant if positive), Enterococcus, Staph and anaerobic gram neg rods
- can also be done c acidometric / iodometric methods
CTX-M B-lactamase - resistance to piperacillin, aztreonam and cefotaxime, but susceptible to ceftazidime
- tx is carbapenem
Metallo-B-lactamase - enzymes hydrolyze all penicillins, all cephalosporins, and carbapenems, bur is susceptible to aztreonam
- present is P aerugenosa and A baumanii
Carbapenemase - MC is Kleb pneumoniae carbapenemase which is resistant to all penicillins, all cephalosporins, aztreonam and carbapenems
AmpC B-lactamase - cephalosporinases, that hydrolyze all B-lactam abx except carbapenems and cefepime
- also resistant to cephamycins (cefoxitin)
- gram negs that have this are Serratia, Proteus, Acinetobacter, Citrobacter and Enterobacter
Extended-Spectrum B-Lactamases (ESBLs) - resistant to extended-spectrum penicillins, 3rd gen cephalosporins, and aztreonam but are susceptible to carbapenems and cefoxitin
- ESBL-making Enterobacteriaceae are a big problem around the world, MC are E coli, K peumonia and Proteus mirabilis
- ESBL-making bugs make the ESBLs c plasmids
- can tx c carbapenems
Other biochemical tests
6.5% NaCl tolerance - differentiate grp D enterococci from group D non-enterococci
- enterococci are tolerant
Bacitracin - differentiate B-hemolytic strep
*** B-BRAS *** Bacitracin - group B strep Resist, group A strep sens ***
Bile-esculin test - Enterococci and grp D non-enterococci (S bovis) can grow in bile
Bile solubility - S pneumonia soluble in bile
CAMP test - id group B b-hemolytic strep
- letters of CAMP stand for its founders
-
Catalase rxn - sees if spp has catalse which converts hydrogen peroxide to H20 and O2
- bubbles indicate catalase presence, done on non-blood agar
*** SPANS KEC ***
Serratia, Pseudomonas, Apergillus, Nocardia, S aureus, Klebseilla, E Coli
CHO utilization tests for Neisseria - differentiate spp of Neisseria based on ability to ferment sugars
Coagulase: separates S aureus (+) form other Micrococcae (neg)
- coagulase is a protein that converts fibrinogen to fibrin
- slide tests finds bounds coagulase, tube test free
Cytochrome oxidase - oxidase activity present if immed turns blue, all Enterobactericiae ox neg
DNAse - Moraxella catarrhalis only gram neg coccus that makes DNAse; allows distinction from Neisseria
Esculin hydrolysis - differentiates Pseudomonas spp
Factor X/V test - classify Hemophilus spp
Flagellar stains - bacteria that have flagella
Hippurate rxn - determines ability to hydrolyze hippurate to glycine
- can give presumptive dx of G vaginalis, C jejuni, L monocytogenes, and GBS
Hugh-Leifson OF media - detects acid production and fermentation
Indole test - determines whether bacteria can split indole from tryptophan, will turn red immediately
- good for gram-neg bacilli id, like E coli (also MAC+) and Edwardsiella (mimics Salmonella [makes H2S])
Methyl red test - mixed acid production or butylene glycol produciton made from pyruvate
- mixed rxn has pH < 4.4, less than red indicator pH
- methyl red positive test is Voges-Proskauer neg, and the reverse is true
Nitrate reduction - all enterobacteriaceae reduce nitrate
- also helps to diff Hemophilus, Neisseria, and Branhamella
Novobiocin susceptibility - distinguishes coag neg staph
*** NO STRESS!!! NOvobiocin: Saprophyticus Resistant, Epidermidis Sensitive ***
Oxidase rxn - detects cytochrome oxidase to id Neisseria (oxidase pos) and differentiate Enterobactericiase (mostly OX neg) from other bacilli like P aeruginosa and Aeromonas (OX pos)
Optochin (P disk) selectively inhibits S pneumonia
*** OVRPS *** Optochin Viridans Resistnant Pneumonia Sensitive ***
PYR reaction - detects pyrrolidnyl arylamidase which is common in S pyogenes, Enterococcus spp, some coag neg Staph, and some Enterobactericiae
Staph streak test - Hemophilus can show satellitism around S aureus 2/2 S aureus ability to synth favotr V and release factor X through hemolysis
String test - V cholera mixed c 0.5% sodium deoxycholate thats strings the innoculating loop
Urease - ammonia release causes red color
- Stuarts broth selective for Proteus, while Christensens broth also detects Klebsiella
Voges-Proskauer - metabolized pyruvate to butylene glycol producing acetyl methyl carbinol, which turns red when mixed c naphtol
- only Klebsiella positive from enterobactericiae
SERUM BACTERICIDAL TEST (SBT) (SCHLICTER TEST)
Indications for Use:
Overview of the Procedure
Interpretation of Results

Blood agar

Chocolate agar



Lowenstein Jenson media

BCYE with legionella



Bacterial Resistance Mechanisms

E test

Gram-negative glucose non-fermenters
- NF comprise about 16% of aerobic or facultative Gram negative bacilli
- 2/3 are Pseudomonas aeruginosa
- Increasing importance in hospitalized patients
- Mostly opportunists (very few frank pathogens)
and found just about anywhere
- Often resistant to broad-spectrum antibiotics
Difficult to identify: biochemically less reactive; (longer reaction times); more fastidious, commercial ID systems often inadequate
Fermentative and oxidative metabolism
Lots of bacteria use carbs to supply energy reqs, while some get energy from other organic compounds
- make neutral or alkaline reaction in CHO media
- Glucose is primary carbon source and is degraded by several metabolic pathways
Embden-Meyerhof-Parnas pathway
- aka "fermentative pathway"
- organic compounds are final electron acceptor
- also called mixed-acid fermentation
- Glucose -> pyruvic acid -> mixed acids + lactic acid
- Glycolytic products from fermentation result in strong pH changes
Entner-Douderoff pathway
- oxygen required for glycolysis, "aerobic pathway"
- Hydrogen is transferred to Kreb's Cycle where it ultimately links with O2 to form H2O
- Glucose -> pyruvic acid -> Kreb's Cycle -> water
- acids formed are extremely weak only detected by sensitive detectors
Warburg-Dickens pathway
- not all "aerobes" are oxidative
- Aerotolerant organisms are capable of growing in O2 but grow best in an anaerobic environment
- HMP pathway means for non-oxidative organisms to degrade glucose to pyruvic acid
- major pathway by which pentose sugars can be metabolized
- Glucose -> pyruvic acid -> mixed acids or Kreb's
- organisms appear fermentative in test systems
Non-fermentative Gram-negative bacilli
NF not well-defined taxonomic group
- only common characteristic is inability to ferment glucose
Clues to recognize of Non-Fermenters
- No acid in butt of TSI or KIA
- Positive oxidase test: however, not all NF are oxidase positive
- No growth on Mac: however, many NF will grow on Mac
Approaches to identification
Triple Sugar Iron (TSI) Slant:
explanation here:
http://www.austincc.edu/microbugz/triple_sugar_iron_agar.php
The King-Weaver Schema
ID charts made by Elizabeth King at CDC, then Robert Weaver
- based on 4 characteristics
1. Glucose Utilization
Enterics media not suitable for NF
- Hugh & Leifson made Oxidative/Fermentative media (OF media) to accommodate NF metabolism
- Contains 0.2% peptone and 1% carbohydrate
- Higher ratio of CHO/peptone enhances acid production
- Semi-solid consistency, bromthymol blue (BTB) indicator
- Two tubes are set up, one is overlayed with miniwax/oil, the other is left open, then incubated in an aerobic incubator
- Fermenters = acid reaction (yellow) in both tubes
- Oxidizers = acid rxn (yellow) in open tube only
- Non-oxidizers = no / alkaline rxn in both tubes
2. Cytochrome Oxidase
Finds cytochromes (Fe containing heme proteins)
- uses colorless dyes in reduced state but turn a dark purple in the presence of cytochrome oxidase & O2
- Kovac's Oxidase reagent: tetramethyl form of
p-phenylenediamine dihydrochloride
3. Growth on MacConkey Agar
Test read as Growth or No Growth (NF appear as NLF)
4. Motility
Semisolid media may not be suitable for some NF
- Inoculate only the top 4-5mm & read in 4-6hrs.
- Hanging drop motility most reliable (HI broth/2hrs.)
- Flagella stains needed to ID some species
5. The CDC King Charts
- Organisms are grouped by characteristics listed above. (OF glu, Mac, Mot, and Oxidase)
Pickett Schema
Uses minimal # of preliminary screening media to quickly ID the most common NF
- Preliminary subculture to KIA slant (heavy inoculum)
- Buffered single substrate media used for most all 20 characteristics
- Secondary characteristics are based on presence of preformed enzymes (results in 4hrs.)
Gilardi's Approach
Practical approach c limited # of tests
- tests are those commonly used for enterics
- MC isolated NF can be identified in 24-48hrs.
Commercial Kits and Systems
- No available kits handle all NF effectively
- Most acceptable for common NF isolates
- RapID NF Plus, API 20E, API NFT, Oxiferm, Corning NF wheel, Vitek AMS, Crystal Ent/NF system, MicroScan WalkAway, and others.
Pseudomonas aeruginosa

Triple sugar iron agar (TSI) is a differential medium that contains lactose, sucrose, a small amount of glucose (dextrose), ferrous sulfate, and the pH indicator phenol red. It is used to differentiate enterics based on the ability to reduce sulfur and ferment carbohydrates.
As with the phenol red fermentation broths, if an organism can ferment any of the three sugars present in the medium, the medium will turn yellow. If an organism can only ferment dextrose, the small amount of dextrose in the medium is used by the organism within the first ten hours of incubation. After that time, the reaction that produced acid reverts in the aerobic areas of the slant, and the medium in those areas turns red, indicating alkaline conditions. The anaerobic areas of the slant, such as the butt, will not revert to an alkaline state, and they will remain yellow. This happens with Salmonella and Shigella.
NOTE:
SIM medium should be read after an incubation of only 24 hours because a longer incubation time can cause a false negative. Vigorous fermenters such as Escherichia coli and Entrobacter cloacae will ferment all the available sugars and then begin using the amino acids. This will produce amine groups and cause the medium to turn alkaline.
If an organism can reduce sulfur, the hydrogen sulfide gas which is produced will react with the iron to form iron sulfide, which appears as a black precipitate. If the precipitate is formed, it can mask any acid/alkaline results. Sulfur reduction requires an acidic environment, so if the black precipitate is present, some fermentation took place. If the butt of the slant is obscured by the precipitate, look at the top of the slant to determine if the organism could ferment only dextrose (red), or if it could ferment either lactose and/or sucrose (yellow).
If the fermentation produced gas, you may see fissures in the medium, or the entire slant may be raised above the bottom of the test tube.
from: http://www.austincc.edu/microbugz/triple_sugar_iron_agar.php

OF Special Media

A = Fermenter; B = Oxidizer; C = non-oxidizer
Mucoid pseudomonas growing on MacConkey

Special testing on bugs
Methicillin Resistant Staph Aureus (MRSA)
If Oxacillin (tested bc more stable than Methicillin) is resistant then resistant to ALL cephalosporins
Mech: MRSA produce Penicillin Binding Proteins (PBP) by way of the mecA gene
- SCCmec is the genetic element carrying mecA which confers methicilllin resistance and is put into the orfX gene via transformation (makes PBP2a)
- Ceftaroline has higher affinity to PBP2a and has >95% activity against MRSA isolates in the USA
- spa gene also specific for S aureus
- Staph Panton-Valentine leukocydin (PVL) is made by lukS and lukF genes assoc c some MRSA stains (USA300 strain)
- vanA gene confers vancomycin resistance
- nuc gene confers resistance to mupirocin and has been used as a specific marker for S aureus
- accessory gene regulator (agr) operon controls S aureus virulence
Tech: Oxacillin put on Mueller Hinton with salt solution (which helps improve detection of resistance)
- cefoxitin used more now 2/2 better sensitivity
Clindamycin Induction (D) test
Detects MRSA sensitivity to Clindamycin
- clindamycin resistance can be easily acquired during tx, thus must test sensitivity to erythromycin and clindamycin
-- the Kirby Bayer zone around clindamycin forms a "D" shape if clindamycin can be induced by erythromycin to become resistant
Vancomycin Resistant Enterococcus (VRE)
All enterococci have inherent resistance to ceph, clinda and TMP/SMX
- BHI and 6ug/ML vancomycin
- is resistant if any growth seen
Synergy c aminoglycosides
- Therapy endocarditis from amp and gent
-- tested by using a 500 mcg/mL single tube screen; if susceptible amp and gent are synergistic
Mech of vanco acquired resistance:
- Plasmid mediated vanA in Enterococcus faecium
- Plasmid mediated vanB in Enterococcus faecalis
-- test is easy
- this is serious bc of rectal colonization in ICU/ long hospitalizations and is serious in immunocompromised pts
Dx: bugs other than VRE can have VanA or VanB genes, causing false pos PCR results (PCR only has 2% PPV)
- not necessary to universally screen for VRE bc colonization rates are very high and is not possible to decontaminate
- the use of VRE selective agar media is the preferred method for screening of VRE carriage
Extended Spectrum B-Lactamase / Klebsiella pneumoniae carbapenamase (ESBL-KPC) production
E coli, Kleb, and Proteus mirabilis are detected by CLSI methods (ESBL double disk test)
- if Tem 1 B-lactamase plasmid (ESBL) activity found must report as ceph / pen resistant and cephalomycin sensitive; treated c imipenem, pip/tazo which block B-lactamase function
Kleb pneumo and other enterics (E coli) make cabapenemase and are hyper-B-lactamase producers (in addition to carbapenem [imipenem] resistance) - screened c ertapenem
- on the Modified Hodge Test for KPC, a positive result if seeing growth up to the meropenem disk
Streptococcus Pneumonia
First, do oxacillin Kirby Bauer disk test
- if resistant to ox then is possibly resistant to Pen (must confirm c MIC)
Second, do MIC Pen test (E test or broth dilution)
- if susceptible can report as Pen susceptible
- if resistant to Pen then must tx c Cefotaxime, vanco or a quinolone
Amplified Gono/Chlamydia test
PCR methods used on samples from multiple body sites
- may utilize for Pap smear then use specimen for PCR (excellent sens/spec)
Chlamydia can be cultured by spinning down shell culture and staining McCoy cells (mouse fibroblasts) c iodine or Direct Fluorescent Antibody (DFA, visualize elementary bodies)
- there is now a molecular binx health io molecular test that is Point of Care that can detect chlamydia and gonorrhea in 30 minutes in the physicians clinic
Clostridium difficile
Gram pos spore-forming anaerobic bacillus
- most important cause of nosocomical diarrhea
- NAP1 strain produces lots of toxins and spores and is hyper-virulent
First phase in testing for C diff is c GDH antigen test and Toxin A and Toxin B test
- if both pos then treat, if both neg then dont, of one pos and one neg then result is indeterminate and must do PCR for tcd and tcdC genes
- GDH ag test uses abs to test for GDH enzyme, a protein present in all C diff (is an EIA)
- Toxin A (enterotoxin) and Toxin B (cytotoxin) detected by Enzyme Immunoassay (EIA)
- tcdB gene encodes Toxin B
- discordant test (different results in first phase c GDH and toxin A and B tests) means that the pt may have an active infx, a nontoxognic C diff infx, or is an asymptomatic carries w/o active dz
In running PCR controls, if (+) control in correct range then assay was done right, if (-) control negative then there was no contamination
- if (-) control is (+) then suspect contamination, and rerun test b4 reporting results
- each test must have an internal control, which can be messed up by Vagasil or zinc, in which case must report as "indifferent" (cant tell [+] from [-])
Molecular testing
16 rRNA gene sequencing
amplifies specific target genetic region to id orgs, but doesnt help if finding out relatedness of strains
Staphylococcal cassette chromosome mec (SCCmec)
the DNA cassette carrying mecA gene determinant for staph, has various variants and subtypes
Peptide nucleic acid fluorescent in situ hybridization
uses probes to hybridize target sequences for microbial id
Pulsed-field gel electrophoresis (PFGE)
Gold standard for genotypic microbial strain typing
- restriction endonuclease digestion forms larger DNA frags
-DNA frags from isolates put in agarose gel lanes and are separated by electrophoresis into distinct band patterns which compares strain relatedness
Matrix-assisted laser desorption/ionization time of flight (MALDI-TOF) mass spectrometry
Proteomics used for microbe id and diff of microbial subtypes within a spp
Micrococcaceae
Catalase positive Gram positive cocci, commonly isolated
Major Groups:
1. Planococcus spp.
2. Micrococcus spp.
3. Stomatococcus spp.
4. Staphylococcus spp.
Only a few cause dz: Staphylococcus aureus, S. epidermidis and S. saprophyticus
Others exist, but don't do too much harm... Stomatococcus mucilaginosus, Staphylococcus haemolyticus, S. hominis, S. warneri, S. saccharolyticus, S. cohnii, S. simulans, S. lugduensis,
S. schleiferi, S. capitis
- S lugdunensis (causes severe infx, >1/2 die) is slide coagulase pos, but tube coagulase neg!!!, (+) PYR and ODC tests
Some may be harmful... S. auricularis, S. xylosis, Rothia mucilaginosa
Found in lots of places: water, soil, skin, food, nose, mouth & lower G.I. Tract
- Rothia mucilaginosa found in upper respiratory tract
- Found in the hospital environment and in hospitalized patients
- Carrier state is common in patients and in hospital personnel
Staphylococcus aureus
B-hemolytic, coagulase +, DNAse +
Sx:
Skin infections: acne, boils, carbuncles, cellulitis, impetigo, post-op wounds, mulluscum contagiosum giganteum, acute epidermal necrolysis (staphylococcal scalded skin syndrome)
- exfoliatin (exfoliative toxin)
Food poisoning: Enterotoxins type A and type B
- Food usually contaminated by food handlers
- Onset 2-6 hrs. after ingestion
- Foods: custards, potato salad, chicken or egg salads, salt cured meats
- caused by ingestion of pre
Community & Hospital Acquired (Nosocomial):
- Bacteremia, endocarditis (native valves, IVDU, tricuspid valve), meningitis, pneumonia, osteomyelitis
Toxic Shock (described in 1978)
- Dramatic increase in 1980 in menstrating women, see fever (>102F), rash + desquamation, hypotension, neg blood cultures/body fluids, >3 organ systems involved (renal, respiratory, hepatic, CNS,,,)
- Associated with use of superabsorbant tampons
- Toxic shock syndrome toxin-1 (TSST-1) c Toxin C (heat labile) and Type F (heat stable) toxins
-- similarly exotoxins A and B (SPEA and SPEB) in s pyogenes activates superantigen production
- Superantigens bind to MHCII and T cell receptor simultaneously causing T cells to release APCs in large numbers
-- blood cultures usually negative bc sx caused by toxins and not by invasive properties of the organism
Dx criteria for toxic shock syndrome: Fever, erythematous macular rash, low bp (<90 mmHg systolic), at least 4 organ systems involved, desquamation during recovery phase, absence of other causes for the sx
Methicillin-resistant S. aureus (MRSA)
Resistant to all β-lactam antibiotics
gram pos cocci in clusters that cause subQ infx leading to necrotizing fasciitis c eschar formation in community acquired infx (MC are USA300 and USA400 as identified by PFGE)
- virulence factors of community-acquired infx include Panton-Valentine leukocidin (an intracellular pore-forming toxin), enterotoxin Q and A variants, a-toxin and enterotoxin B
- Evolving problem (hospital & community acquired)
- About 1% of the population carries MRSA
- Spread → skin-to-skin contact, openings in skin, contaminated items & surfaces, crowded living conditions, poor hygiene
- skin infx can lead to nec fasc, nec pneumonia, bad sepsis, Waterhouse-Friedricksen syndrome
- Prevention → handwashing most effective
- Methods are available to rapidly detect MRSA in the lab
Tx: Vancomycin is drug of choice for MRSA
Coagulase-Negative Staphylococci
Staphylococcus epidermidis
Septicemia in patients with prosthetic devices, implanted valves/shunts, subacute bacterial endocarditis by forming biofilms
- novobiocin sensitive, coagulase negative
Staphylococcus saprophyticus
Urinary tract infections in young women
- novobiocin resistant, makes white chalky colonies
- even growth of a few colonies (10^2-3) significant
Other coagulase-negative Staphylococci
- Bacteremia, endocarditis, IV catheters, joint protheses, peritonitis, osteomyelitis, genitourinary tract infections
Dx: Gram Stain: Gram positive, round, somewhat oval, pairs, singly, or in clusters
- Salt tolerance: 7 - 10% (Staphylococcus spp.)
- Catalase positive
DX:
Coagulase:
1. Slide method:
- Organism + rabbit plasma on slide
- Read within 10 sec. for clumping
- 10-15% of S. aureus are slide negative
- Tests for "bound" coagulase or clumping factor
2. Tube method:
- Broth culture + rabbit plasma
- Incubate at 35 C for 4 hrs. and look for clotting
- Tests for bound and free coagulase
- Perform on all isolates with a negative slide test
Hemolysis:
- Most S. aureus isolates are β-hemolytic
Novobiocin:
- 5 μg disk (read for zone of inhibition)
- S. saprophyticus is resistant (others are sensitive)
Carbohydrates:
- Used to determine acid production using anaerobic sugars with brom- cresol purple or brom thymol blue
- S. aureus ferments mannitol unlike S. epidermidis
- Mannitol salt agar (MSA) used commonly
Colonial morphology/Pigment:
- Most S. aureus, some S. saprophyticus, and rarely S. epidermidis produce a yellow to orange pigment
DNase:
- Plating media with DNA and a dye (methyl green or methylene blue)
- If DNA is hydrolyzed by DNase the area surrounding the organism turns colorless
- most S aureus are DNase (+)
Thermostable Endonuclease Test:
- Dnase test medium with toluidine blue O
- Holes are bored into the agar and inoculated with a broth suspension of organism that has been boiled for 15 min.
- Plate is incubated overnight at 35○C
- S. aureus will show a pink zone around well
Other Catalase - (+), Gram - (+) Cocci
Rothia mucilaginosa
- Resident of the human upper respiratory tract (oral cavity); formerly stomatococcus mucilaginosus
- Endocarditis and septicemia secondary to cardiac catheterization and intravenous drug use
- Most patients have serious underlying disease
- Clear to white mucoid colonies that adhere to agar surface (sticky staph)
- Large Gram positive cocci in pairs or clusters
- Catalase is usually weak (some strains may be negative, others strongly positive)
- No growth on Nutrient Agar with 5% NaCl
- Large encapsulated Gram positive cocci
- Positive Reactions: VP, Gelatin, Glucose, Sucrose, Fructose, Salicin
- Negative Reactions: Alkaline phosphatase, Mannitol, Sorbitol, Coagulase
Micrococcus spp.
Gram + cocci in tetrads; Usual flora of human skin, mucosa, and oropharynx
- Rarely implicated in human infection
- Usually considered as contaminants, probably of very low virulence
- May cause infections in immunocompromised
- When infections occur agents are most likely endogenous strains
- susceptible to most antibiotics (bacitracin)
- Microdase positive (modified oxidase test)
- Non-hemolytic, many strains pigmented (bright yellow, white, tan, orange, pink) in tetrads
Catalase positivity

Staphylococcus gram stain

Staphylococcal carbuncle

Staphylococcal furuncle ("boil")



Mulluscum contagiosum giganteum
Staphylococcal scalded skin syndrome


S aureus virulence factors
S epidermidis - bacitracin resistant, fuazolidone susceptible


S saprophyticus with zone of inhibition on novobiocin test


Thermostable endonuclease test c Staph Aureus showing pink zone
Staph colonies on plates: left is the yellow colonies of S aureus, right are the coag neg colonies

Passive hemagglutination (staphyloslide) test showing sensitized sheep blood agglutination, indicating clumping factor and protein A

Rothia mucilaginosa - like pushing around snot

Enterococcus (Group D)
- resistant to single agents, esp broad-spectrum abx
- Usual flora of G.I. tract
- cause 1/10 UTIs and 1/5 endocarditis, bacteremia in pts c long-term indwelling catheters
- also neonatal septicemia and meningitis (like GBS)
- MCC is E. faecalis, then E. faecium
- E. Faecium is more resistant than E. Faecalis
- E. Casseliflavus is yellow pigmented,
- E. Gallinarum is motile
- bile esculin (+), grows in 6.5% NaCl, PYR (+)
-- S bovis does not grow in 6.5% NaCl
- Vancomycin resistance acquired from plasmids
- VRE transfers resistance to other bacteria (MRSA)
- 1/3 recent Enterococcus caused by VRE
- MCC of VRE is E. faecium (also abx resistant), and E faecium also causes lots of UTI in elderly in long-term care / nursing facilities and hospitals
- VRE causes variety of difficult to tx infections
- although may appear susceptible to cephalosporins, clindamycin, TMP-SMX, and aminoglycosides (except for high-level resistance screening) in vitro, these antimicrobials have not proven to be of clinical efficicacy in vivo
Aerococcus spp.
- envtal contaminants; seen in pts c SBE and UTIs
- 1% of systemic streptococcal infections
- Aerococcus urinae gram + cocci in pairs and tetrads, PYR-neg, LAP +, vanco susceptible
- Aerococcus viridans in pairs and tetrads is PYR positive, LAP negative, vancomycin susceptible
Gemella spp.
- a-hemolyic, isolated from blood
- PYR positive, LAP +, BEA neg, 6.5% NaCl negative
- Susceptible to vancomycin
- Gram positive cocci in pairs and short chains
- Gemella hemolysans easily decolorized and may appear as a Gram negative diplococci
Pediococcus spp.
- 8 spp, mostly in plants, also fecal flora in human dz
- PYR negative, Lancefield Gp. D antigen, BEA +
- Resistant to vancomycin
Lactococcus spp.
- L. garviae seen in human dz
- Susceptible to vancomycin, PYR negative (except L. garviae)
- α-hemolytic or non-hemolytic
- Previously Lancefield Gp. N
- Sensitive to vancomycin
Leuconostoc spp.
- Envtal isolates (plants, soil), human dz in immunocompromised hosts
- Septicemia & meningitis, also wounds and UTI
- Leucine amino-peptidase (LAP) negative, vanco resistant, gas from glucose, PYR negative
- Usually in pairs or chains
Nutritionally Variant Streptococci
- seen in blood and body fluids
- Blood culture media will support growth
- grows on chocolate agar or BAP if supplemented with pyridoxyl hydrochloride (vit B6)
- 5-6% of microbial endocarditis
- satellites around Staphylococcus spp., yeasts, E. coli, Klebsiella spp. and some Enterobacter spp.
- Abiotrophia devectiva , Granulicatella adiacens, and Granulicatella elegans
Streptococcus pyogenes (Group A Strep)
B-hemolytic Gram-pos cocci in chains, PYR+, cause pharyngitis, humans are natural reservoir, catalase neg, bacitracin susceptible
- Transmission associated with carriers and food
- dz can be superficial, invasive, toxin-mediated or postinfectious
- Dz in man include; scarlet fever, sinusitis, arthritis, osteomyelitis, meningitis, and skin infections, erysipelas (spreading infx of skin/mucous membranes
- Numerous virulence factors
- MCC of bacterial pharyngitis (overall is viral)
- Flesh eating bacteria (rapid tissue destruction)
- Complications from Ag-Ab reactions include Rheumatic Fever and post-Streptococcal glomerulonephritis
-- **Rheumatic fever - 2 words - Type II HS **
-- ** Post-Strep GN and SSSS > 2 words - HS III **
- Rheumatic fever occurs after strep throat, NOT the skin infx; the skin infx or pharyngitis can lead to post-strep GN 10 days to 2 wks post-infection
- JONES criteria for rheumatic fever
- Joints, Carditis, Nodules, Erythema marginatum, Sydenham's chorea
Virulence factor is M protein, capsule; hyaluronic acid, strptolysin O (O2 labile) and streptolysin S (O2 stable), streptococcal progenic exotoxins
PYR test is a rapid stop test that can reveal GAS or enterococci (poor sensitivity, culture should be taken if rapid strep test neg)
Streptococcus agalactiae (Group B Strep; GBS)
B-hemolytic, CAMP+, hippurate hydrolysis+
- Most significant human pathogen in neonates
*** B for Babies ***
- Neonate exposed while passing through birth canal
- Early and late onset neonatal disease
- Neonatal dz: respiratory distress & meningitis
-- also causes dz in infants & children, and adults
- Screening tests available for vaginal colonization during pregnancy
- normal vaginal flora seen in 1/4 of women
Dx: cocci in chains on Gram stain, B-hemolytic
- positive bottle culture
Streptococcus pneumoniae
a-hemolytic Gram (+) lancet-shaped diplococci c polysaccharide capsules major virulence factor
- About ninety capsular types by Quellung reaction
- Spread by respiratory secretions
- MCC of otitis media & bacteremia in infants/children
- Major cause of pneumonia and meningitis
-- 1/10 have as usual flora, so lots of false + sputums
- Pneumonia; rusty-colored sputum with numerous pus cells, typical pneumonia in non-hospitalized pts, usually (>50%) assoc c bacteremia
- Also conjunctivitis, sinusitis, and arthritis
- Can be usual flora of upper respiratory tract
- Compromised hosts most susceptible
Dx: rapid urine ag test
- bile susceptible, a-hemolytic, optochin sensitive
*** OVRPS (overpass) Optochin - viridans resistant . Pneumoniae susceptible ***
Tx: High-dose penicillin G or 2nd/3rd gen ceph
- Vaccine available against the 23 most common serotypes (23-polyvalent Pneumovax)
Viridans Streptococci
- Diverse group, α-hemolytic, optochin resistant, bile resistant
- Opportunistic pathogens, low virulence
- cause dental caries (S mutans) and SBE (S sanguis)
- 10-12 species are usual flora of the oral cavity
- MCC of SBE (subacute bacterial endocarditis)
- Frequently implicated species include; S. sanquis, S. mitis, S. intermedius, and S. mutans
Other Streptococcus spp.
Lancefield Group C Streptocci
- S. equisimilis is species most often associated with human infection, but usually veterinary
- Pharyngitis, tonsilitis, pneumonia, endocarditis, bacteremia
Lancefield Group D Streptococci (not Enterococcus)
- S. bovis (aka gallolyticus) bacteremia assoc c colon cancer in adults
- Must differentiate from Enterococcus spp.
Lancefield Group F Streptococci
- S. anginosus causes abcess formation in patients
with underlying disease or antecedent trauma
- Cervicofacial, dental, and intraabdominal abcesses
Lancefield Group G Streptococci
- May be usual flora of pharynx, G.I. Tract, vagina, and skin
- Bacteremia & endocarditis in patients with malignancies,
diabetes, alcoholics, and I.V. drug abusers
Streptococcus iniae
- major fish pathogen causing invasive disease and outbreaks in aquaculture farms
- The organism has virulence factors similar to Gp. A Strep and can be transferred to and cause infection in humans
- An emerging zoonotic pathogen associated with injuries acquired while preparing whole fresh fish for cooking
- Soft tissue injuries resulting in bacteremic cellulitis of the hand then endocarditis, meningitis, arthritis, sepsis, pneumonia, osteomyelitis, and toxic shock
- MC in elderly patients with one or more underlying conditions and of Asian descent
● B-hemolytic, PYR+, CAMP+, no Lancefeld group
Streptococcus dysgalactiae subspp equisimilis (SDSE)
Pharyngitis in teens/young adults
- tests neg in rapid strep test (specific for GAS)
- has same virulence factors as GAS
- GAS negative strep tests should be backed up c culture
Streptococcus anginosus
has groups C and G small colony variants
Lab Identification
Presumptive Tests
Hemolysis
- Affected by composition of basal medium & type of blood used
- Atmospheric conditions important (streak plates/pour plates)
- Streptolysin S (O2 stable) and Streptolysin O (oxygen labile)
- Types of haemolysis; α (partial lysis), β (complete), γ (non-hemolytic), and α-prime
- can stab plates to help with hemolysis
Bacitracin Disk
- Taxo A disk (0.04 units bacitracin)
- Used to differentiate Gp. A Streptococcus from other
β-hemolytic Strep
*** B-BRAS - Bacitracin - group B Resistant, group A Sensitive ***
CAMP Test
- β-lysin producing Staphylococcus aureus enhances hemolysis with Gp. B Streptococcus
- positive for GBS
Hippurate hydrolysis
- Hippurate hydrolysis positive for GBS
- Deep purple color is positive
- Ninhydrin reagent
Bile-esculin and 6.5% NaCl
- Only Enterococcus spp. normally (+) for both
Optochin Disk
Taxo P (Optochin) disk used to differentiate S. pneumoniae (pos) from other α-hemolytic species
- must measure the zone
*** OVRPaSs - Optochin - Viridans Resistant, Pneumoniae Sensitive ***
Bile solubility
- Based on accelerated autolysis of S pneumoniae in presence of bile salts
- 2% sodium desoxycholate
PYR Test (L-pyrrolidonyl-β-naphthylamide)
- Hydrolyzed by S. pyogenes and Enterococcus spp.
- Red color is positive
- Cinnamaldehyde reagent
SXT (TMP-SMX)
- S. pyogenes and S agalactiae are resistant
- 1.25mg trimethoprim + 23.75mg sulfamethoxazole Disk
Confirmatory Tests
Serological procedures: antisera made against Lancefield or "Grouping" antigens of the Streptococci
Coagglutination:
- Utilizes Staphylococci as the carrier molecule for anti- Streptococcal antibody
Latex agglutination:
- Uses latex particles as carriers of anti-Strep abs
Rapid Strep Tests
Test for presence of Streptococcal antigen to Gp. A Strep and Gp. B Strep

(+) - Staphylococcus---

Strawberry tongue in scarlet fever of s pyogenes
Bacterial pharyngitis caused by S pyogenes



Pyoderma caused by S pyogenes
Necrotizing fasciitis c s pyogenes

Strep pyogenes

Group B strep

S pneumonia gram stain



Gram-(+) Bacilli: Non-spore formers
Corynebacterium spp.
Gram positive rods, No spores, Pleomorphic (club shaped, beaded, granules, "Chinese characters", etc.); Aerobic, microaerophilic, facultatively anaerobic, Catalase Positive
- urease can help differentiate C diphtheriae and C ulverans
***CHYNEbacterium for the CHYNEse (Chinese)***
- Normally live in soil, plants, air, skin, mucous membranes, nasopharynx
- considered contaminants, but some strains can be opportunistic pathogen [Corynebacterium diphtheriae (diphtheria); Corynebacterium ulcerans (diphtheria, pharyngitis / associated with horses and cattle); Corynebacterium jeikeium (Gp. JK) (found on skin, urine / enodcarditis, tracheitis, pneumonia, lung abscess, UTI, multi-drug resistant); Corynebacterium urealyticum (Gp.D2) (alkaline encrusted cystitis, UTI, wounds)]
- other spp. Corynebacterium: C. amycolatum, C. pseudodiphtheriticum; C. striatum
Corynebacterium diphtheriae
Sx: Diphtheria - fever, spread by carriers, pseudomembrane formation
- Exotoxin - generalized intoxication, affects kidney, heart, nervous system
- has an ADP ribosylating A-B toxin that inactivates elongation factor-2 (EF-2) [just like Pseudomonas exotoxin A], causing pharyngitis and pseudomembrne
- Non-toxigenic strains exist
- Cutaneous Form - tropics and N.W USA + Canada
*** ABCDEFG - ADP ribosylation, B-prophage, Corynebacterium Diphtheriae, Elongation Factor-2, metachromatic Granules ***
Dx: Swab from inflammed areas of throat & nasopharynx ???
- Cutaneous (wounds): Swabs or aspiration
IHC: Gram stain: Burke's Modification
- Granule stains: Loeffler's & Albert's
- Microscopic morphology:
Morphology influenced by biotype, media, stain used
Pleomorphic, beaded, pointed or rounded ends, coccoid to long rods, metachromatic granules
Culture: Three types of colonies described; (mitis, intermedius, gravis)
- Media (Loeffler's medium, Cystine tellurite)
-- Tindale media: tellurite, sodium thiosulfate, cystine (forms a brown halo)
*** It's hard to TELL HER IT (tellurite) with Coryne in you throat ***
Biochemistry: brown halo on Tinsdale, Glucose fermenter, nitrate +, maltose +, sucrose +, non-motile, urease -
- C. ulcerans also produces a halo on Tinsdale (nitrate -,urea+)
- C. pseudotuberculosis can produce a halo as well (nitrate+, urea+)
Toxigenicity testing:
- In vivo → inoculation of rabbits & guinea pigs
- In vitro → ELEK Plate (virulence agar + filter paper & antitoxin)
Tx: prevented c vaccine (DTaP - diphtheria toxoid, pertussis, and tetanus toxoid); get booster c 10 yrs
Listeria monocytogenes
Causes abortion, stillbirth, meningitis
- Meningitis & septicemia in older children and adults
- short rods to coccobacillus (chains / pairs too)
- Lives in lots of mammals and birds in gut
- caused by unpasteurized dairy, deli meat ingestion, vaginal transmission during birth
- only gram-(+) c endotoxin
- has virulence factors such as actin, hemolysins, and internalins
- Cold enrichment is questionable
- Facultative anaerobe, grows well on infusion agar
- BAP = narrow diffuse β-hemolysis
- McBride's media = blue/green colonies
- Catalase + (vs Strep), Esculin +, VP positive, hippurate +
- Umbrella motility (room temperature incubation)
Tx: oenicillin or ampicillin, no susceptibility test reqd
Erysipelothrix rhusiopathiae
Found just about everywhere,
- causes dz in pigs (erysipela) and humans that work with animals [erysipeloid (self limiting lesions)]
Histo: short, straight, slender, curved rods
- can be found in filaments
- Tendency to decolorize easily
Culture:
- Biopsy material
- Grows well on BAP, Infusion broth + 1% glucose
Identification:
- Oxidase & Catalase negative, non-motile
- H2S positive on TSI (unique for gram + bugs)
Gram-(+) Bacilli: Spore forming
Bacillus spp.
Found in all parts of nature; usuallly in soil or as dz in insects, or opportunistic infx
- Large box-car shaped rods with spores in chains
- May stain gram negative
Bacillus anthracis
Gram-(+) spore-forming rod infections in man may be cutaneous (black eschar), pulmonary (Woolsorter dz), or GI and are caused after exposure to infected animals or animal products (occupational disease)
- now very rare in the U.S., though occasionally seen in terorist attacks (sent in the mail)
Histo: Large bacilli with square ends in chains (box-car- shaped)
- Oval subterminal spores
- Virulent forms have capsules; may be gram negative
-- only bacteria c polypeptide capsule (D-glu)
Culture: Non-motile,nitrate positive, sensitive to 10u Penicillin, VP+
- BAP = no hemolysis, ground glass colonies with comma shaped outgrowths or swirling projections (Medusa head colonies)
- May be difficult to separate biochemically from other Bacillus spp., especially Bacillus cereus
Bacillus cereus
Sx: Common cause of food poisoning
- Two forms of food poisoning: emetic and diarrheal
- Emetic form: short incubation period, preformed toxin, heat stable, assoc c reheated rice dishes
- Diarrheal form: longer incubation period, heat labile enterotoxin, assoc c meats & vegtables
Culture: Poo, puke, food (10^5 orgs/gm of food)
- BAP = β-hemolysis, motile, resistant to 10u Penicillin, positive for starch hydrolysis
Misc. Aerobic Gram-(+) Bacilli
Lactobacillus spp.
Common isolate, very low pathogenicity
- seen in vagina, GI, mouth (mucous membranes)
Histo: Varies greatly from long slender filamentous rods to short coccobacilli
Rxns: Catalase negative, non-motile
Arcanobacterium haemolyticum / pyogenes
Frequently isolated from throat cultures
- β-hemolytic on BAP, can be confused with Streptococcus pyogenes
- A hemolyticum is gelatin negative, A pyogenes is (+); A pyogenes is more rare than A haemolyticum
- Can cause pharyngitis, abcesses, septicemia
- Diphtheroid morphology, catalase negative
Rothia dentocariosa
Normal flora in human mouth
- Assoc c abcesses and endocarditis
- Catalase positive, branching filaments on solid media, VP+, esculin (+), nitrate (+), spherical cells in broth
Gardnerella vaginalis
Normal flora in many women though assoc c Bacterial Vaginosis (formerly non-specific vaginitis)
- significant in high numbers
Dxing bacterial vaginosis depends on:
- vaginal pH above 4.5
- vaginal discharge thin, homogenous, milk-like consistency
- "fishy smell" when 10%KOH added to vaginal discharge (whiff test)
- presence of "Clue Cells"
- replacement of Lactobacillus -dominated flora
*** I have no clue why it smells like fish in your vagina garden ***
Can be found with other anaerobes (Mobiluncus spp. Bacteroides spp. etc.)
- may cause maternal / neonatal septicemia, postpartum bacteremia in association with caeserian section or abortion
Dx: Cervical, urethral, or vaginal specimens from infected women
- Swabs inoculated directly onto media or placed in transport media
- Growth on V-agar or HBT agar (sensitive) plates (both agars have human blood)
- Media incubated at 35 C in 5-10% CO2 for 48hrs.
- Gram variable - Gram negative to Gram positive, small, pleomorphic coccobacilli, some with pointed ends, catalase negative
- Isolates on both HBT and V-agar are β-hemolytic while showing no hemolysis on BAP (differential hemolysis)
Histo: Wet mount or Gram Stain smear
- "Clue Cells" on wet mount
C diphtheria - pseudomembranes

C diphtheriae - bull neck

C. diphtheria


C diphtheria -Brown halo on Tinsdale

C. diphtheria: ELEK plate (in vitro toxigenicity test)

Listeria monocytogenes (gram)

Listeria monocytogenes c weak diffuse B-hemolysis on BAP

L monocytogenes c umbrella motility at room temp

Erysipelothrix skin infx

Erysipelothrix gram stain

Erysipelothrix - look at the H2S in the tube's butt!!

Bacillus c central and subterminal spores

B anthracis c rough, non-hemolytic colonies that stand up

Eschar of cutaneous anthrax



B cereus: large B-hemolytic colonies on BAP
Lactobacillus


Lactobacillus - growth on BAP
A haemolyticum gram stain


A haemolyticum on BAP
Adherent gray discharge of bacterial vaginosis


Anaerobes
Oxygen is toxic to these guys
- Microaerophilic - can tolerate a little O2
- Aerotolerant - tolerate O2 well
- Obligate Anaerobe - do not grow in presence of O2, may be subclassified as moderate or strict OAs
- infx 2/2 endogenous organisms (anaerobes MC than aerobes in mouth, lower GI, vagina, skin and mucosa (1/5 bacteremias, 9/10 brain abscesses, 1/2 chronic sinusitis, 100% aspiration pneumonia, 9/10 lung abscesses, 1/2 bite wounds)
What does O2 do to anaerobes you ask?
2 important enzymes (aerobes have both):
1. Catalase - removes H2O2 (a toxic substance)
2. Superoxide Dismutase - converts O2- (a superoxide radical) to O2 and H2O2
- CLUES: bad odor, close proximity to a mucosal surface, bites, gas, aminoglycoside use, black discoloration of blood-containing exudates, "Sulfur Granules" in discharges, unique morphology on Gram Stain (orgs on Gram Stain that dont grow anaerobically), growth in anaerobic zone of fluid or semi-solid media
Identification
- Anaerobic chambers / jars (have paladium catalyst that dries over 2 hours), bags
- PreReduced Anaerobically Sterilized (PRAS) Media -- use pH to measure CHO
- Rapid Microtechniques (Rapid Kits and Identification Systems)
- Preliminary Grouping based on Special Potency Disks
Gas-Liquid Chromatography
- Helium is the carrier gas
- has Flow regulator, Sample Injector, Oven with separating column, Thermal Conductivity Detector, Strip Recorder
Principles of operation
- Ether / Chloroform extracts
- Temperature range 140-150C
- Timing of peak = identity of compound
- Height of peak = amount / quantity of compound
- Flow rate: 120cc / min.
Sample preparation
- Peptone Yeast Glucose broth
- Ether extract + H2SO4 ( volatile acids)
- Chloroform extract + H2SO4 (methyl derivatives of non-volatile acids)
Interpretation of results;
a) Volatile Acids: Acetic, Formic, Propionic, Butyric, Isobutyric, Valeric, Isovaleric, Caproic, Isocaproic
b) Non-volatile Acids: Pyruvic, Lactic, Fumaric, Succinic
Gram Negative Anaerobes
Gram negative bacilli
1. Bacteroides spp. 3. Prevotella spp.
2. Porphyromonas spp. 4. Fusobacterium spp.
Gram negative cocci
1. Veillonella spp.
2. Acidaminococcus
3. Megasphaera
Bacteroides Fragilis
Anaerobe, gram neg, causes intra-abdominal infx
- bad odor indicated anaerobe
Includes: B. fragilis, uniformis, thetaiotaomicron, stercoris, vulgatus,caccae, distasonis, merdae,
ovatus, eggerthii
- MC org in large intestine, causes peritoneal abscess if gut lining damaged
- has a capsule, endotoxin and succinic acid (inhibits phagocytosis)
1/3 of all clinically isolated anaerobes
- resistant to penicillin and 20% bile
- esculin positive
- BBE (Bacteroides Bile Esculin media)
- resistant to Kanamycin, Vancomycin, and Colistin (almost all make B-lactamase); need combo drugs to tx (ampicillin-sulbactam...)
-- oral & dental infections, ear, nose, mouth, head, neck, skin & soft tissue infections, lungs, pleural space, female genital tract, intraabdominal infections, CNS, cardiovascular, bone & joint infections
Bile-sensitive Pigmented Gram negative Bacilli
Porphyromonas spp. (asaccharolytic)
a) P. asaccharolytica
b) P. endodontalis
c) P. gingivalis
Prevotella spp. (saccharolytic)
a) P. melaninogenica d) P. denticola
b) P. intermedia e) P. loescheii
c) P. corporis
- fluorescence under U.V. light
- brown to black pigment on anaerobic BAP
- KVLB (Kanamycin-Vancomycin-Laked-Blood media)
- Prevotella melaninogenica is most frequently isolated
- involved in a wide variety of clinical infections
Bile-Sensitive Non-Pigmented Gram Negative Bacilli
1. Bacteroides - has same disk pattern as Fubobacteria and can corrode the agar
2. Prevotella
3. Tissierella
- resistant to Kanamycin, sensitive to 20% bile
- no dark or black pigment on BAP
- sensitive to 20% bile
- divided into groups based on CHO fermentations and requirement for formate or fumarate
Fusobacterium
F. nucleatum, naviforme, necrophorum, gonadiaformans, mortiferum, russii, varium, pseudonecrophorum, ulcerans
MC are F. nucleatum & F. necrophorum
- F. nucleatum : spindle-shaped cells, gread-crumb colonies, indol +, lipase negative
- F. necrophorum : pleomorphic swollen cells, ground-glass colonies, indol +, lipase +
- F. mortiferum & F. varium are resistant to penicillin and clindamycin
F necrophorum can cause up to 1/10 cases of tonsilitis in adolescents not caused by group A strep
- can also cause peritonsillar abscess and Lemierre syndrome (infx of posterior compartment of lateral pharyngeal space causing thrombophlebitis of jugular vein that can seed the lungs)
Anaerobic Gram Negative Cocci
1 .Veillonella -V. parvula, V. atypica, V. dispar
2. Megasphaera elsdenii
3 .Acidaminococcus fermentans
- assoc c oral, bite wound, head & neck, soft tissue infections
- MC is Veillonella parvula (indole neg, nitrate +)
- GLC essential to differentiate between genera
- Megasphaera elsdenii may appear Gram positive
- Veillonella may fluoresce red under U.V. light
Gram Positive Anaerobes
Gram Positive Bacilli
1. Clostridium spp. 5. Propionibacterium spp.
2. Actinomyces spp. 6. Mobiluncus spp.
3. Bifidobacterium spp. 7. Lactobacillus spp.
4. Eubacterium spp. 8. Eggerthella lenta
Clostridium
- Cl. tertium & Cl. histolyticum are aerotolerant
- Cl. novyi & haemolyticum are strict anaerobes
- some species may appear Gram negative
- found in soil, marine environments, intestinal tract of man and animals
- most infections arise endogenously
- botulism, tetanus, gas gangrene are exogenous in origin
The Gas Gangrene Clostridial group
a) Cl. perfringens type A e) Cl. histolyticum
b) Cl. septicum f) Cl. sordellii
c) Cl. novyi type A g) Cl. sporogenes
d) Cl. bifermentans
- Clostridial myonecrosis
- deep wounds, foreign bodies, failure of blood supply, proteolytic enzymes
- MC is Clostridium perfringens
- Clostridium sordellii is only urease positive species
- Cl ramosum 2nd MCC
- Cl septicum assoc c malignancy and necrotizing enterocolitis in neutropenic patients
Pathogenic Clostridia
Clostridium tetani --> Tetanus
Clostridium botulinum --> Botulism
Clostridium difficile --> Antibiotic-associated colitis & diarrhea
Miscellaneous Infection Group
a) Cl. perfringens d) Cl. sphenoides
b) Cl. ramosum e) Cl. sporogenes
c) Cl. bifermentans
Clostridium perfringens
- 1/2 of all Clostridial isolates
- five types based on toxins produced (types A - E)
-- Type A responsible for most human infections and food poisoning
- alpha- toxin (lecithinase) causes gas gangrene and hemolysis
- short plump rod, non-motile and boxcar-shaped rods, no spores on most media, aerotolerant
- double-zone hemolysis, lecithinase positive, Nagler test positive
Clostridium difficile
Gram pos, anaerobic, spore-forming bacillus
- antimicrobial-agent induced pseudomembranous colitis
- enterotoxin (exotoxin A) causes mucosal inflam and GI fluid loss
- Exotoxin B (cytotoxin) depolymerizes actin filaments causing GI mucosal cell death and pseudomembranous colitis
-- new strand BI/NAP1/027 toxintype III more resistant to fluoroquinolones and more virulent 2/2 inc toxin A and B production, inc sporulation and polymorphisms in toxin B binding domain
- nausea, vomitting, watery or bloody diarrhea, abdominal pain, cramps
- good selective media available
-- CCFA (cycloserine, cefoxatin, fructose, egg yolk agar)
- isolation from stool = presumptive only
- must demonstrate toxin to confirm diagnosis, done c stool toxin assay or PCR
- bc of low sens, toxin EIA tests should not be used as stand alone diagnostic modalities for toxigenic difficile
Tx: metronidazole or vanco PO
Clostridium tetani
- causes tetanus following puncture wound
- sx 2/2 neurotoxin that causes lockjaw
- blocks release of GABA and glycine (inhibitory neurotransmitters)
- dx based on clinical grounds
Clostridium botulinum
- causes botulism
- neuroparalytic dz caused by very potent toxin
-- makes preformed heat-labile toxin that inhibits ACh release at NMJ
- four categories of botulism;
1. Food borne botulism (ingestion of preformed toxin)
2. Wound botulism
3. Infant botulism (spore ingestion in honey)
4. Undetermined
- seven toxigenic types ; A - G (A,B, E, and F in human infections)
- blocks acetylcholine release, causing anticholinergic sx, CNS paralysis (esp cranial nerves)
- spores in canned food and honey (floppy baby)
Gram Positive Non-Spore Forming Bacilli
Actinomyces
Normal flora, causes of human actinomycosis, facial abscesses that can drain through sinus tracts in skin
- Actinomyces israelii is most important species
- branching Gram positive rods, Sulfur granules, Molar tooth colonies
Bifidobacterium
- Bifidobacterium dentium only pathogenic spp
- dental caries, feces, vaginal
- Y-shaped forms, clubs, filaments, very pleomorphic
- nitrate negative, ferments Glucose
Eubacterium
- five named species; Eggerthella lenta (previously Eubacterium lentum) is MCC
- usual flora of G.I. tract, questionable pathogenicity
- pleomorphic bacilli, coccobacilli, short plump rods, short chains
- biochemically inactive, GLC recommended to differentiate species
Propionibacterium
- Propionibacterium acnes most frequently isolated Gram positive non-spore forming rod
- indole positive, catalase positive
- most frequent contaminant of blood cultures
- usual flora of skin and G.I. tract, can cause endopthalmitis, prosthetic valve endocarditis, CNS shunt infx
- pleomorphic, branched, diphtheroid morphology
Mobiluncus
- Gram positive c.w. structure but usually stain Gram negative
- associated with nonspecific vaginosis
- oxidase negative, catalase negativ, indol negative
- curved Gram negative rods
Gram Positive Cocci
1. Peptostreptococcus spp. (anaerobius)
2. Peptococcus spp. (niger)
3. Streptococcus spp.
Gram Positive Anaerobic Cocci
Peptostreptococcus
- MC spp are P. magnus , anaerobius , and asaccharolyticus
- Peptostreptococcus anaerobius is sensitive to SPS disk
- Peptostreptococcus magnus may be involved in infections of prosthetic devices and is biochemically inert (and is now called Finegoldia magna)
- Peptostreptococcus asaccharolyticus is indol positive, nitrate negative, and stains Gram variable
Peptococcus
- Peptococcus niger is the only species in the genus
- rarely isolated from clinical material
- produces black colonies, GLC = major butyric acid & caproic acid
Streptococcus
- anaerobic Streptococci differentiated from Peptostreptococci by lactic acid production
- the anaerobic Streptococci include Streptococcus parvulus, Streptococcus hensenii, and Streptococcus pleomorphis


B fragilis in anaerobic cellulitis in DM

B fragilis

Porphyromonas c red fluorescence in UV light

Bacteroides ureolyticus pitting the agar
Bread crumb colonies and greening of agar of F nucleatum

Fusobacterium

Clostridial gas gangrene of abd wall

Clostridium perfringens - double zone hemolysis

C difficile pseudomembranous colitis

Infantile botulism


Aerobic Actinomycetes
Nocardia
Partially acid fast, aerobic, gram pos, chalky on agar
- identified to the spp by 16S rRNA, hsp65, rpoB, and secA genes
- Lives in soil and plant material, hospital envt, seen mostly pneumonia in immunocompromised pts, high mortality in disseminated dz (>50%)
-Long thin branching Gram positive rods
- closely related to mycobacteria
Nocardia asteroides (MCC) has been reclassified into several spp such as N cyriacigeorgica, N farcinica, N abscessus, N nova complex, and the N transvalensis complex
Nocardia caviae (N. otitidis-cavarum)
Nocardia brasiliensis
(former) Nocardia asteroides
Causes pulmonary infections, systemic infections that can affect brain & meninges
- can disseminate through blood or direct extension
- 3/4 of cases in males
Nocardia brasiliensis
Mycetoma: Draining pus through sinuses (subcutaneous), chronic suppuration, granules
Nocardia cyriacigeorgica
gram pos partially acid fast filamentous branching rod that forms white colonies c aerial hyphae and grows w/in 3 days
Dx: culture (of sputum, pus, biopsy, CSF)
- Direct Exam: Gram stain, wet mount, acid-fast (partially Acid-Fast)
Culture and Identification
- Media: BAP, Chocolate agar, Sabouraud-Dextrose agar (SAB), Lowenstein-Jensen slant, 7H11 agar
- Incubate at 27 C to 30 C for two weeks
- Colonies appear in 3 to 30 days
Biochemical Tests
Gram Stain Casein hydrolysis, Acid-Fast Stain, Xanthine, Slide culture, Tyrosine, Litmus, Milk Growth in 0.4% gelatin, Sugar fermentation, Urea, Catalase, variable growth temperature (4 C, 22 C, 37 C, 42 C)
Chromatography, Cell wall analysis
Tx: Sulfonamides; TMP/SMX
Streptomyces spp.
Also live in soil, plant material, sometimes animals
- considered a saprophyte
Penetrating wounds / skin abrasions can cause myecetoma
- can also cause chronic granulomas
Useful bc have aided in the development of abx
(Streptomycin, Nystatin, Chloramphenicol, Antivirals
Tetracycline, etc)
Labs: non-acid fast, lots of delicate branches c spores and chains, waxy heaped colonies, susceptible to lysozyme (Nocardia resistant to lysozyme)
Actinomycetoma
Chronic suppuration c draining sinuses of subcutaneous tissue caused by bacteria
- a Eumycetoma is 2/2 fungi
Actinomadura madurae: large soft white-yellow-red granules
Actinomadura pelletieri: soft small granules, deep red
Nocardia asteroides: rare small soft white-yellow granules
Nocardia brasiliensis: as above but granules are common
Nocardia caviae: same as N. asteroides
Streptomyces somaliensis: hard yellow-brown granules
Streptomyces paraguayensis: black granules
Rhodococcus equi
cause respiratory dz in humans (also soft tissue infections) and pneumonia and abortion in horses
- Most human cases are in immunosuppressed pts
Dx: Light pink or coral colored colonies
- Gram positive coccoid to branching rods
- Acid fast in parts of their life cycle
- Catalase positive, have capsules, non-hemolytic, non-motile
Miscellaneous Actinomycetes
Oerskovia spp.
- Aerobic gram positive bacilli found in the soil
- Formerly CDC Coryneform Groups A1-4
- Two species, O.turbata & O. xanthineolytica
- Variety of clinical sites, low virulence
Dermatophilus congolensis
- Causes a pustular, exudative dermatitis (dermatophilosis)
- Also causes foot rot, pitted keratolysis, streptotrichosis in many species of animals
- Infrequent human isolate
- Pathology → masses of non-Acid Fast, branching septate filaments in
hair follicles or in the soles of the feet
Tropheryma whipplei
- 1st described in 1907, then characterized in 1991 using n.a. amplification + sequencing
- Gram positive rod related to Rothia, Rhodococcus,
Streptomyces, Arthrobacter, etc.
- Small genome, deficient in energy metabolism & certain a.a.
Humans are possible reservoir (human feces & sewage)
- seen in duodenal biopsies in patients w/o Whipples disease
- DNA detected in saliva & gastric secretions as well
Whipples disease - a rare, chronic, multisystem disease
- G.I. tract most often affected (also joints, nervous system, etc.)
- Heart can also be involved → a cause of culture-negative Endocarditis
- A facultative intracellular pathogen found in foamy macrophages containing numerous bacteria within vacuoles
- negative AF stain, never been cultured
- Immunologic staining of tissues, tissue culture, n.a. amplification required for definitive identification
Anaerobic actinomycetes
Actinomyces spp.
Seen in skin and mucous membranes (esp mouth)
Anaerobic branching Gram positive rods, tend to fragment into short rods, chains, and coccobacillary forms
- Filaments are 1μm or less in diameter
Actinomyces bovis
Actinomyces israelii
Actinomyces naeslundii
Actinomyces odontolyticus
Bifidobacterium eriksonii
Chronic suppurative and granulomatous infection
- Pyogenic lesions with interconnecting sinus tracts containing granules (sulfur granules)
- Can penetrate bone and cause osteomyelitis
Types of infection
Cervicofacial (MC), Thoracic, Abdominal, genital
Dx:
Direct Exam - yellow "sulfur granules" to be crushed, then do Gram stain and culture
Specimens for culture
- Pus, tissue, body fluids, material from drainage sites
Culture and ID: Need enriched anaerobic media
- "Spider colonies" and "Molar Tooth colonies"
- Identify using anaerobic bacteriology methods
Tx: Penicillin, Tetracycline, erythromycin, chloramphenicol, show activity in vitro

N brasilensis - foot mycetoma

N brasilensis - leg mycetoma

Casein hydrolysis - Nocardia


Nocardia
Streptomyces
Streptomyces colony


Actinomycetoma

Rhodococcus equi c salmon-colored colony (arrow)
Dermatophilus congolensis



A israelii - oral dz

Actinomyces israelii

Molar tooth colonies


Spider colonies
Neisseriaceae
Previously included several spp (Neisseria, Moraxella, Acinetobacter, Kingella)
Several new classification schemes have been proposed
- divided into Neisseriaceae & Moraxellaceae
- Gram negative cocci and diplococci in pairs (can be single or in tetrads) with flattened adjacent sides
- Non-spore formers, non-motile, some c capsules
- Complex growth requirements, biochemically inert
- Oxidase Positive, Catalase positive
- live in nucous membranes of warm-blooded animals and man
- Some species are found as normal flora in the nasopharynx and oropharynx
- Neisseria gonorrhoeae and Neisseria meningitidis cause sx and only infect humans
***MeninGococci ferments Maltose and Glucose, Gonococci only ferments Glucose ***
Neisseria
Neisseria spp.
MC found in the nasopharynx
- Referred to as the "saprophytic Neisseria"
- Low virulence, must be distinguished from pathogenic species
- Includes; N. sicca, N. subflava, N. mucosa, N. weaveri, N. elongata
Neisseria lactamica
Seen in nasopharynx of infants & children
- Rarely causes infx
- Biochemically like N. meningitidis but is lactose (ONPG) positive
Neisseria cinerea
Normal flora of upper respiratory & genital tracts
- blamed in some nosocomial infections
- usually glu neg, but sometimes glu pos
- Can be confused with N. gonorrhoeae
Neisseria animaloris
Only ferments glu, indol neg, arginine pos, sometimes has tan-yellow color
- smells like popcorn
Neisseria meningitidis
Found in throat & nasopharynx of carriers, 8-20% (reservoir), highest in older children & young adults (20-40%)
- Spread by person-to-person contact, found only in humans
- Disseminated infection results in meningococcemia and/or meningitis
- Observed primarily in infants, 3mo. to one year, and older adolescents & young adults (college kids)
- Crowded conditions predispose to spread of disease & large outbreaks occur in military bases
-- Chemoprophylaxis c rifampin or cipro routinely used to treat contacts
- has polysaccharide capsule, ferments maltose, vaccine can be made, can cause Waterhouse-Friedrickeson syndromr
Purpura fulminans from meningococcemia causes extensive areas of tissue destruction, shock → death
- Quadrivalent vaccine recommended for at risk individuals (A,C,Y,W135)
- Divided into 13 serological groups using capsular or cell wall antigens groups include A,B,C,D,X,Y,Z,29E, W135
- Isolates from carriers are often nongroupable
- Isolates causing epidemic and sporadic disease are grouped by multilocus
isoenzyme electrophoresis typing (ET groups) as well as clonal subgroups
Dx: presumtive dx made on direct gram stain of CSF
- Growth on MTM, NG on Nutrient Agar or at 22 C, Glu+, Mal+, DNase negative
- Serotyping can be done in some cases
- Direct detection of meningococcal antigen in CSF & Blood
Tx: can prevent with rifampin (turns everything orange), ciprofloxacin, ceftriaxone
- vaccine is available
Neisseria gonorrhoeae
One of the MCC communicable diseases in U.S.
- Seen only in humans, are not normal flora
- Pts usually <25 yrs. of age
- STD or transmitted during birth (ophthalmia)
- can affect joints or cause PID and be life-threat
- no capsule, does not ferment maltose, no vaccine, sexually transmitted
- NAAT used for rapid detection in urine
Males: Usually symptomatic in 3-4 days
- Sx: yellow pus discharge and painful urination
- Males will usually seek medical treatment
Females: mostly asymptomatic
- Cervical involvement, vaginal discharge
- Complications: PID, ectopic pregnancy, tubal scarring, infertility
Dx: Nuclei acid amplification Test (NAAT) is most sensitive and accurate
Direct Microscopy
- Males: Gram stain urethral discharge
-- negative smears cultured
- Females: Gram stained cervical smears doesn't usually help
-- usual flora has many saprophytic Neisseria spp.
-- need culture to dx
Culture- obtain from urethra in males, cervix in females
- there is now a molecular binx health io molecular test that is Point of Care that can detect chlamydia and gonorrhea in 30 minutes in the physicians clinic
Specialized media:
MTM: Modified Thayer Martin (Vancomycin, Colistin, Nystatin, Trimethoprim lactate
- VPN agar (Vancomycin [for gram (+), Polymyxin for gram (-), Nystatin for fungi)
*** in order to get into your VPN client, you must be Neisseria ***
Martin Lewis: (Vancomycin, Colistin, Trimethoprim lactate, Anisomycin)
New York City Medium: (Lysed horse blood, Vancomycin, Colistin, Trimethoprim, Amphoteracin B)
Environmental Conditions: 2-3% CO2 , moist atmosphere, CO2 incubator / bags, 35 C, 24-48 hrs.
Transport Media: swab transport system, Transgrow, Jembec plate, etc.
Colonial morphology: Opaque, grey-white, clear, granular, convex, mucoid, usually 1-4mm in diameter
Presumptive Identification
- Superoxol test helpful
- Oxidase Reagents: Dimethylparaphenylene diamine hydrochloride, and Tetramethylparaphenylene diamine dihydrochloride
-- Oxidase reagent added directly plated colonies
- don't use Nichrome loops (gives false (+))
- can be pleomorphic on Gram stain 2/2 reagents
- Morphologically typical, oxidase positive colonies growing on selective media, may be reported out as “Gram negative oxidase positive diplococci
resembling Neisseria gonorrhoeae” if isolated from urogenital sites
Confirmatory Identification
- Not required on every culture suspected of being G.C.
- Must consider source, age, medical-legal implications, etc.
- Any isolates from a child must be confirmed by at least two methods
- Carbohydrate degradation using Cystine Trypticase Agar (CTA)
- CTA Sugars - Semi-solid media with phenol red indicator & 1% carbohydrate (glucose, maltose, sucrose, lactose, fructose) also ONPG
-- ONPG can be substituted for lactose
- Rapid Fermentation Test (RFT) utilizing preformed enzymes
- Commercial Kits & automated systems: biochemicals, fluorescent Ab, coagglutination, Gonogen II., etc. (rapID NH, QuadFerm, Vitek Neisseria Card, API NH, etc.)
- DNA Probe Tests & PCR assays also available
- Serological approaches (Meritec G.C.)
Tx: broad spectrum cephalosporins
- penicillinase-producing strains (PPNG) appeared around 1976
Chlamydia
Obligate intracellular bug that can't make its own ATP
- Elementary bodies are Enfectious and Enter cells via phagocytosis
- Reticulate bodies Replicate in cell by fission
- cell wall weird bc lacks muramic acid
- NAAT is the most organisms-specific test
Chlamydia trachomatis
MCC of STD in the USA!! (N gonorrhea is 2nd)
- causes urethritis (noes not have a discharge), reactive arthritis and conjunctivitis) and PID
- up to 1/3 are co-infected c gonorrhea
Subtypes:
A, B, C = African blindness, chronic infx, trachomas
D-K = neonatal pneumonia, exctopic preg, PID
L1-L3 = lymphogranuloma venereum (acute lymphadenitis [is NOT granuloma inguinale (donovanosis) caused by Calymmatobacterium granulomatis]), makes stellate microabscesses very similar to cat scratch dz
Tx: oral erythro
Chlamydophila pneumoniae
Atypical pneumia, assoc c adult onset asthma
- use serology to detect IgM titer >1:16 or 4x inc in IgG, culture is gold standard (but not always available)
Chlamydophila psittaci
Atypical pneumonia assoc c pet birds
- enter respiratory tract and multiples in liver and spleen
Moraxella catarrhalis
Clinical Significance
- Once considered to be a saprophytic Neisseria
- low virulence→ not usually pathogenic
- now considered "emerging pathogen"
- causes acute otitis media, sinusitis, meningitis, endocarditis, pneumonia, especially in children and pts c underlying lung dz
- 3rd MCC childhood ear infections
- Infections seen in elderly adults with COPD (bronchitis, pneumonia, etc.)
- Serious infections in immunosuppressed patients
- Growth on Neisseria media is variable
- Current research on vaccines for pathogenic strains
Dx: Gram negative, aerobic, oxidase-positive diplococcus, typical Neisseria- like morphology (presents in pairs & tetrads on Gram stain)
- variable growth on selective media
- Grows at 22 C and nutrient agar at 35 C
- Inactive in carbohydrates (CTA sugars)
- DNase positive
- Butyrate esterase test positive (Cararrhalis test disk – Remel)
- β-lactamase positive (95%)
- antimicrobial susceptibility not routinely done for Moraxella catarrhalis bc empiric tx usually sufficient, but bc the majority make beta-lactamase, they are resistant to ampicillin and amoxicillin
Tx: Augmentin, second & third generation Cephalosporins, Erythromycin, Ciprofloxacin, Gentamicin, etc.

*** The first letter of the name says what it is positive for

N meningitidis - CSF gram stain

Neisseria meningococcemia

N gonorrhoeae


Gonorrhoea - direct gram stain from male pt


N gonorroeae colonies on MTM

Transgrow flask
CTA sugars




M catarrhalis - (+) butyrate esterase




Haemophilus
- Pleomorphic Gram-negative bacilli, non-motile, nitrate positive, oxidase positive
- Obligate parasites, usual flora of respiratory tract and mucous membranes
- Requirement for one or both of two factors present in blood (X [hematin] and V [NAD+]) in chocolate agar
Haemophilus influenzae
- First isolated from sputum of influenza patient
- Normal flora of nasopharynx = carriers
- Upper & lower respiratory tract infections (epiglottitis), septicemia, osteomyelitis, endocarditis, pericarditis, arthritis, sinusitis, otitis media, pneumonia
- G.I. and GU isolates, causing UTI
- Nosocomial pulmonary pathogen
Children esp at risk: H. influenzae type b (Hib) in nasopharynx cause otitis media
- life threatening if cause epiglottitis
- also causes cellulitis and septic arthritis
Haemophilus influenzae biogroup aegypticus
- Acute contagious purulent conjunctivitis, seasonal epidemics of pink eye
- Brazilian purpuric fever (may result in death)
- H. influenzae biotype III is almost identical
Haemophilus ducreyi
Causes chancroid or "soft chancre" a venereal disease
- Occurs mostly in males, prostitutes are important reservoir
- Characteristic lesion, enlarged lymph nodes, suppurative buboes
Haemophilus parainfluenzae
- Endocarditis and biliary tract infections, meningitis
- Usual flora of respiratory tract, dental plaque, rarely pathogenic
Haemophilus aphrophilus and Haemophilus paraphrophilus
- Rarely pathogenic, cases of endocarditis
- now called Aggregatibacter
Haemophilus haemolyticus and Haemophilus parahaemolyticus
- Upper respiratory tract flora, rarely pharyngitis, endocarditis
- β-hemolytic on rabbit or horse blood agar
Direct exam
- CSF: centrifuge nad make smear of sediment and Gram stain, looking for Gram-neg cocco-bacilli or short rods
-eyes- Gram stain may be helpful
- genital ulcers / LNs: Gram stain generally not helpful
Specimen of choice
- Haemophilus influenzae : CSF/Ears/Eyes site of infection
- Haemophilus ducreyi : Genital ulcers
Culture and Isolation
Maemophilus = "Blood Loving"
- fastidious, requirement for growth factors / X factor = hemin, V factor = coenzyme I, nicotinamide adenine dinucleotide (NAD)
- Grow well on chocolate, grow poorly or not at all on BAP (sheep blood)
- Heating blood (chocolate) releases V factor and destroys NADase
- Will grow on rabbit or horse blood (dont make NADase), some strains hemolytic
- Grow best at 35C, moist atmosphere, under CO2
- Colonies small, grey, opaque, smooth, some mucoid
- Taxonomy based primarily on growth factor requirements:
X only = H. ducreyi
V only = H. parainfluenzae parahaemolyticus
X and V = H. influenzae, aegypticus, haemolyticus
- species of Haemophilus that begin c "P" (parainfluenzae, parahemolyticus, pittmaniae, and paraphrohaemolyticus) are neg for X factor and pos for V factor
Determination of Growth Factor Requirements:
1. Incorporate growth factors into a clear media
2. Use of growth factor strips or disks
3. Use a V-factor producing organism on BAP & a clear media
Special considerations for Haemophilus ducreyi
1. Use chocolate agar + isovitalex + vancomycin
2. Use rabbit blood + isovitalex + vancomycin
3. Adding 10% fetal calf serum may help
4. Incubate for four days at 33-35C, high humidity, increased CO2
Other differentiating factors
- H. influenzae has eight biotypes based on Indol (IND), Urea (URE), and Ornithine (ORN)
- H. parainfluenzae also has eight biotypes based on the same tests
- Hemolysis on rabbit/horse blood + C02 dependence
- H aphrophilus doesnt need either X or V factors
Porphyrin
- Strains that do not require X factor convert α-aminolevulinic acid (ALA) to porphyrins
- Inoculate organism into ALA broth, incubate, read for red fluorescence (can also use ALA disks)
- H. influenzae requires X factor = porphyrin negative = no fluorescence
- H. parainfluenzae does not require X factor = porphyrin positive (red flourescence)
Serological Considerations
- 6 serotypes of H. influenzae (a-f) that are based on capsular Ags
- Virulence assoc c presence of a capsule
- Most isolates are non-typeable (no capsule)
- Serious infections (meningitis) are usually type b
- Non-typeable strains can still cause infections
Tx
- prevent c vaccines in kiddos18 months or older
- Newer vaccines now available for infants two months old
- up to half H. influenzae strains resistant to ampicillin 2/2 plasmid-mediated ß-lactamase
- β-lactamase testing recommended for all clinically significant isolates
- Third-generation cephalosporins are used to treat serious infections (cefotaxime & ceftriaxone)
- Ceftriaxone or erythromycin are used for chancroid
Pasteurella
Pasteurella multocida
- Usual mouth flora in animals
- Primarily a pathogen of animals causing septicemia
- Human infections: bite or scratch wounds from dog or cat, also be acquired by handling carcasses
- occasional human pulmonary infections (sputum)
- Isolated from blood, CSF, brain abscesses, etc.
Culture Characteristics
- Grows well on media containing blood or hemin
- Grows poorly on EMB or MAC
- Grows best aerobically
- Colonial morphology: small, transluscent colonies,
non-hemolytic, greenish discoloration of blood
- Smooth or rough colonies, colonies from dogs may be pigmented
- Characteristic odor (mousy)
Microscopic appearance
- Small Gram negative rods, predominantly coccobacilli
- Single cells, pairs, most have capsules
- Bipolar staining
- Pleomorphic in healthy tissue
- Shorter, more typical in diseased tissue
Biochemical Characteristics
- Catalase positive, Oxidase positive, Indol positive
- Usually no reaction in OF Glucose but organisms are glucose fermenters (weak reactions)
- TSI = Aw/Aw after 48hrs.
Pasteurella pneumotropica
- Usually isolated from rodents, dogs, and cats
- Rare in humans
Pasteurella dagmatis
- Associated with dogs and cats
- Formerly Pasteurella new species I.
- Produces gas from carbohydrates
Pasteurella aerogenes
- Associated with swine, animal bites, urine
- Peritoneal fluid in humans
- Gas from glucose, grows on MAC
- Rapidly urea positive
Mannheimia haemolytica
- Pneumonia in sheep, cattle, goats and URT of poultry
- Human infections are rare
- β-hemolytic, urea negative, indol negative
Sottonella indologenes (Kingella indologenes)
Can be part of human flora, cause rare ocular infx
- can spread or pit surface of blood agar
Other animal bites
Human bite - Eikanella corrodans
Dog bite - Capnocytophagia canimorsus
Cat bite - Pasteurella multicida
Postorbital cellulitis in kiddo c pus that had S pneumoniae and Hib

Hib septicemia

H ducreyi buboes

Satelliting of Hemophilus spp



Haemophilus "Quad plate"

P multocida infx from cat bite

Spot Indol test - blue-green color means that it is positive


Pseudomonas and related organisms
Classified by rRNA Homology Groups, the organisms are then classified by biochemistry
- 15 other families also Non-Fermenters
- for dx, NFB are dealt with according to similarities in biochemical tests
Commonly encountered Pseudomonas Spp
Fluorescent Group Pseudomonas spp.
- Glucose oxidizers, Oxidase positive, produce pyoverdin, Arginine hydrolysis positive
Pseudomonas aeruginosa
MC NF, aerobe, motile (polar monotrichous flagellum), long slender gram neg rod, B-hemolysis and metallic sheen on sheep blood
- ubiquitous, secondary invader, corneal perforation, resistant to broad spectrum abx
- assoc c Cystic fibrosis, nosocomial infections (burn pts [also S auerus, Enterobactericiae, Acinetobacter]), corneal perforation, swimmer's ear (external otitis), diabetic osteomyelitis, UTIs, ventilator pneumonia, endocarditis, endochonditis, folliculitis
- P aeruginosa in CF pts more mucoid from alginate overproduction
- has an ADP ribosylating A-B toxin that inactivates elongation factor-2 (EF-2) [exotoxin A]
Dx: Pyocyanin + pyoverdin production, polar flagella, glu oxidizer, Mac +, 42 C, grape odor, ADH+, Nit+, Nit gas+, motile , ground glass colonies, mucoid colonies involved in cystic fibrosis patients (mucoid colonies very unreactive biochemically) , variety of pigments (green, yellow, red, brown)
Tx: 2 bx - aminoglyco + extended spectrum penicillin
Pseudomonas fluorescens & Pseudomonas putida
Opportunists, questionable significance
P. fluorescens : I.V. fluid contamination
P. putida : hospital env. rare UTI
Dx: polar flagella, no pyocyanin, no growth at 42 C., no gas from nitrate, Ps. putida is gelatin negative, Ps. fluorescens is positive in 2/3
Burkholderia pseudomallei
primary pathogen, MELIOIDOSIS, uncommon in U.S.
pulmonary form MC, enters through skin, can be dormant, variable clinical picture, “Vietnamese time bomb”, rapidly fatal
Dx: glu oxidizer, Oxidase +, older colonies wrinkled (fried egg), variety of pigments, 42 C growth, nit+, nitrate gas+, motile
- vs p aeruginosa, B pseudomallei does not make pyocyanin or pyoverdin, utilizes lactose, acetamide negative, resistant to polymyxin
Burkholderia mallei
Glanders in horses, man rarely infected, occupational disease, acute & chronic forms
Dx: Oxidizer, Oxidase +w, non-motile, no growth at 42 C, no gas from nitrate, Arginine +
Burkholderia cepacia
(several organisms comprise the B. cepacia complex)
Slow-growing, non-lactose fermenting gram neg bacillus that is weakly / variably oxidase pos
Sx: opportunist, hospital enviornment, endocarditis,
UTI, pneumonia, conjunctivitis, blood cultures
- bad respiratory dx in cystic fibrosis pts, esp in older teen and adult groups
- resistant to lots of abx
Dx: Oxidase variable, glu oxidizer, motile, lysine +, arginine -, pigments
Tx: has lots of resistance, need susceptibility testing
Ralstonia picketii
part of Burkholderia, not normal flora, can be found in lots of places in nature (suspect envt'l contamination)
Dx: glu oxidizer, oxidase (+), nitrate (+), urease (+), negative decarboxylases, grows at 42 C, mac growth variable
Stenotrophomonas maltophilia
Sx; opportunist, 2nd MC pseudomonad, endocarditis, septicemia, pneumonia, eye infections, meningitis, gunshot and other wounds, etc.
Dx: oxidizer (may be late or weak in Glucose), maltose +, oxidase -, lysine +, Gelatin +, ONPG+
- greening on BAP
Stutzeri group Pseudomonads
Pseudomonas stutzeri
Sx: opportunist, usual flora, compromised hosts
Dx: Oxidizer, oxidase +, motile, gas from nitrate, Dry wrinkled colonies, arginine (+)
Pseudomonas mendocina
Sx: soil & water organism, sometimes in urine
Dx: arginine +, oxidase (+), glu oxidizer, growth at 42 C
Shewanella putrefaciens
Uncommon opportunist, putrefaction of butter, meat, fish, many environmental sources
Dx: Two biotypes recognized, glu oxidizer, oxidase +, motile, H2S in TSI
Alcaligenes group pseudomonads
Pseudomonas alcaligenes & Pseudomonas pseudoalcaligenes
Sx: environmental isolates, variety of clinical sources,
questionable significance
Dx: non-oxidizer, oxidase +, motile, 42 C growth
P. pseudoalcaligenes gives weak rxn in OF fructose
Brevundimonas diminuta and Brevundimonas vesicularis
Opportunists, many environmental sources, clinical sources include blood, CSF, urine, throat, etc.
Dx: non-oxidizers but P. vesicularis may be
weakly positive in OF glucose, oxidase +, motile
Pseudomonas-like organisms
Sphinogmonas paucimobilis and S. parapaucimobilis
Opportunists, hospital environment, many clinical sources, sputum, CSF, wounds, urine, blood, vagina, cervix, etc.
Dx: No growth on Mac, oxidizers, oxidase +,
motile at 18-22 C, non-motile at 37○C, esculin positive, yellow pigment, ONPG+, DNase +
- S. paucimobilis → Citrate negative, Lead Acetate negative
- S. parapaucimobilis → Citrate positive, Lead Acetate positive
Pseudomonas eye infx
P aeruginosa growth on BAP



P aeruginosa c Kirby Bauer test (Mueller-Hinton plate) - c green pigment

P aeruginosa growin on BAP in a pt c cystic fibrosis- mucoid colonies, pigment


Glanders in horse infected c Burkholderia mallei

B pseudomallei fried egg colonies
Stenotrophomonas maltophilia greening on BAP

Pseudomonas stutzeri dry wrinkled colony

Shewanella putrefaciens H2S (+) in TSI / KIA agar slants
Enterobacteriaceae
- Gram negative, motile (peritrichously flagellated) asporogenous, facultatively anaerobic rods
- Glucose fermenter (acid or acid and gas)
- Oxidase negative, nitrates normally reduced to nitrites
- DNA homology (70% or greater = same species)
~ 120 species and 30 genera
- MC aerobic or facultative Gram negative bacilli, isolated in from any body site (usually intestine)
- all are opportunistic, some cause acute dz (Salmonella, Shigella, and Yersinia, some E coli spp)
Pathogenesis
Endotoxins
Toxicity 2/2 the lipid A portion of the lipopolysaccharide (LPS) portion of the cell wall
- causes fever, leukopenia, septicemia, shock
Enterotoxins
- polypeptides that affect sm intestine
- Cholera toxin is the classic example
- plasmids in E. coli may code for enterotoxins
- factors involved in pathogenesis: invasiveness, adhesion, colonization factors and others!!!
Antigens
a) Flagellar antigens
- flagellin protein, H antigens (heat labile)
-- may be useful in distinguishing Salmonella from other motile enteric organisms
b) Capsular antigens
- Polysaccharides, K antigens (heat labile)
- virulence may be related to presence of capsule
c) Somatic antigens
- cell wall LPS (repeating sugars) and O antigens (heat stable)
Plating Media
Selective Media (bismuth sulfate [BS], salmonella shigella [SS], Hektoen enteric [HE/HEK], XLD)
- CIN agar selects out Y. enterocolitica
Differential Media (MacConkey [MAC], eosin methylene blue [EMB])
- based on biochemical characteristics (ie. lactose fermentation)
Incubation of plates
- incubated at 35C in aerobic (non-CO2) incubator
- Most enterics have detectable growth in 24hrs
Enrichment Broths
Enteric enrichment broths are designed to select for the presence of Salmonella spp.
- Selenite F, Tetrathionate, GN broth, Rappaport broth
Biochemical Tests
1. Oxidase (enterics are oxidase negative), OF Glucose (enterics are glucose fermenters)
2. Triple sugar iron (TSI), Lysine iron agar (LIA), and Urease, indol, citrate agar
3. Other biochemicals
D. Interpretation Of Results
1. Flow Charts (examples from text)
2. Percentage Charts (examples from text)
3. Computerized approaches
Escherichia coli
"Normal" E. coli strains
- Indol positive, lactose positive, gas from glucose
- Motile, acetate positive, urease negative, citrate negative
- VP negative, H2S negative, no phenylalanine deaminase
- TSI: A/AG (yellow/yellow c bubbles)
- LIA: K/K (red/red) or K/A (red/yellow)
-- results interpreted as slant/butt
"Inactive" E. coli strains
- Non-motile, no gas from glucose fermentation
- Lactose not fermented (or is slow / weak)
- biochemically similar to Shigella
Pathogenicity
Enterotoxic E Coli (ETEC) - travelers diarrhea (Montezuma's revenge) and infantile diarrhea by plasmid mediated toxins (Labile Toxin, Stable Toxin a, Stable Toxin b)
- LT similar to cholera toxin
- heat-labile toxin stimulates Adenylate cyclase, and heat-stable toxin stimulates Guanylate cyclase
*** Labile like Air, Stable like Ground ***
Enteroinvasive E. coli (EIEC)
Makes shiga-like toxin and causes dysentery (bloody)
Enteropathogenic E. coli (EPEC) - bad diarrhea in hospital nurseries
Enteroaggregative / enteroadherent E. coli (EAEC)
Shiga-Toxin producing E Coli (STEC)
- formerly Enterohemorrhagic E. coli (EHEC) - E. coli O157:H7 causes hemorrhagic colitis / hemolytic uremic syndrome (HUS) or hemorrhagic colitis
- also has shiga-like toxin and can cause dysentery
- HUS triad: microangiopanthic hemolytic anemia, renal failure and thrombocytopenia, usually kids <5yo, 1/20 dies
- found in uncooked ground beef (2014)
- incubation period from a few days to little over week
- Stx1 and Stx2, aka verotoxins, produced
- ferments lactose but NOT sorbitol, grows on sorbitol-MAC (SMAC) as a colorless colony
- MCC infx-related kidney failure in peds, 1/20 die
- not able to ferment on the sorbitol fermentation
E. coli O104:H4, C227-11
- outbreak in Europe in early Summer 2011
- was a combo of Enteroaggregative E. coli (EAEC)and Shiga-toxin producing enterohemorrhagic subtype
- quinolone causes toxin production, which is encoded by a phage
- could be acquired in Egyptian fenugreek seeds
Pathotypes of E coli (by molecular analysis)
Uropathogenic E coli (UPEC) - causes UTIs
MeNingitis E Coli (MNEC) - neonatal meningitis
Escherichia albertii
Diarrhea, nausea, fever in Bangladesh kids in 2003 and Japanese restaurant 2011
-can make a Shiga-toxin; no lab tests yet
- Positive Rxns; ONPG, Acetate, Lysine, Ornithine, Gas from Glucose, Arabinose, Mannitol Ribose
- Negative Rxns; Indol, Motility, Arginine, Lactose, VP, H2S
Escherichia fergusonii (human blood & feces, urine)
Escherichia hermannii (human wounds, feces) yellow pigment
Escherichia vulneris (human wounds, most are yellow)
Escherichia blattae (no human isolates)
Citrobacter
Normal flora in H20 and poop, but can cause UTI, septicemia, sinusitis, burn infx, pneumonia
- Nosocomial infections: implicated in gastroenteritis and neonatal meningitis
Pathogenic spp
Citrobacter freundii
- Indol negative, H2S positive, Malonate negative
- May be confused with Salmonella
Citrobacter koseri (diversus)
- Indol positive, H2S negative, Malonate positive
Citrobacter amalonaticus
- Indol positive, H2S negative, Malonate negative
Edwardsiella
Edwardsiella tarda
GEitis in tropical places, septic shock, hepatic abscesses, meningitis, wounds, cellulitis
- Primary reservoirs are cold and warm blooded animals (reptiles & fresh water fish) [aquarium fish]
- Biochemically similar: Citrobacter and Salmonella
- H2S positive, citrate negative, malonate negative, Indol positive
Edwardsiella tarda biogroup 1
- Mostly in snakes
Edwardsiella hoshinae
- Birds and reptiles
Cedecea
3 species: Cedecea davisae, Cedecea lapagei, Cedecea neteri
- Clinical significance uncertain
- May cause bacteremia and scrotal abcess
- Biochemically similar to Serratia spp. but are Dnase negative + Gelatin positive
SMAC agar

Salmonella
50k cases per annum in USA, mostly from chicken, raw milk and exotic pets
- very young and old at risk
- 15% of food-borne illness in U.S.
- 1-2 day incubation period
- Gastroenteritis, Enteric fever (S typhi and paratyphi), bacteremia, septecemia, metastatic infx or asymptomatic carrier state
- motile (Salmon swim!) c flagella, H2S-producing, grown on MacConkey-Hektoen enteric agar
- black pigmentd on XLD agar 2/2 H2S
- O antigen - outermost part of LPS cell surface
- H ag - in the flagella
- Vi ag - capsular polysaccharide in some type
Gastroenteritis
- accounts for >3/20 food-born dz in USA; 1 day incubation period
- Salmonella sainpaul caused oubreak in 2008
- diarrhea, cramps, NV
- no tx; resolves spontaneously in a week
Enteric Fever
Multiorgan infection c fever, bacteremia caused by typhoid bacillus (S. typhi) and paratyphoid strains
- S. typhi found only in man
Sx: Fever can persist for weeks when untreated
- Rose spots (faint rash)
Dx: blood culture
Tx: Vaccines available, chloramphenicol / other abx helpful
Bacteremia and Metastatic Infection
Bacteremia can accompany acute gastroenteritis
- S. cholerasuis classical causative agent, Gp. C, H2S negative
- Colonization of structural abnormalities & meninges
Dx: blood culture
Asymptomatic Carrier State
Salmonella can persist in stool / urine, reculoendothel cell spleen, liver and gallbladder are reservoirs
- may be seen after infection or even after asymptomatic dz
- 1/20 recovering gastroenteritis patients shed the organism 20 months later
- Typhoid Mary: Food handlers are important reservoir of infection
- failure of tx common
Spp subgroups / subspp classified by DNA homology:
- Subgroups I-IV. and VI are Salmonella enterica
- Subgroup V is Salmonella bongori
- subgroups II-VI rarely in humans (except IIIa)
Subspecies I: S. Enterica subspecies enterica
- 98-99% of all human isolates
- O groups A, B, C1, C2, D, E1, E2, E3, E4
- MCC: S. typhimurium & S. Enteritidis
Subspecies II - S. salamae
- Cold-blooded animals, environment
Subspecies III.a - S. arizonae
- Cold-blooded animals, environment
- Occasional diarrhea in man
Subspecies III.b - S. diarizonae
- Cold-blooded animals, environment
Subspecies IV - S. houtenae
- Cold-blooded animals, environment
- Rarely pathogenic for humans
Subspecies V - S. bongori
- Cold-blooded animals, environment
- O group F
Subspecies VI. (S. indica)
- Cold-blooded animals, environment
Non-typhoid Salmonella
- TSI=K/AG+, LIA=K/K+, lactose negative, gas from glucose, hydrogen sulfate positive
- Citrate positive, motility positive, Ure negative, Indol negative
- Decarboxylases normally positive, VP negative
Salmonella typhi
- TSI=K/A+, LIA=K/Awk., Ornithine negative, gas not produced from glucose, citrate negative
- MultiDrug-Resistant Typhoid Fever (MDRTP)
- vaccines available but not recommended
Serological Characteristics
- Based on both O and H antigens
- S. typhimurium - Gp.B
- S. typhi - Gp.D with Vi ag (heat labile capsular Ag
Tx: Spontaneous recovery in 1 week
- tx not recommended (can use cipro, but resistant strains emerging)
Shigella
Resembles E. coli biochemically and DNA profile
- invasive; only found in human large intestines, spread amongst humans, assoc c poor hygiene in H20, non-motile
- S sonnei and flexneri the MCC in USA, 1/2 seen in kiddos (<5 yo), 2/3 in those <10 to
- highly infective (need only few organisms to infect
- all spp can cause bacillary dysentery, severity is spp dependent
- can go outside GI and cause Bacteremia, meningitis, pneumonia
- Shiga toxin (also made by E coli0157H7) inactivates 60S/23S ribosome in host rRNA causing HUS through cytokine release
Sx: fever, cramps, painful watery diarrhea, bloody stools
- 1-3 day incubation period
- dehydration is serious complication esp in kiddos
*** from most to least severe: Dont Forget Body Scrub*** Dysenteriae, Flexneri, Boydii Sonnei ***
Shigella dysenteriae (subgroup A)
Most severe form of shigellosis
- mannitol negative
Shigella flexneri (subgroup B)
Common isolate in U.S. (about 15% of cases)
- ONPG negative
Shigella boydii (subgroup C)
Severe infection mostly in tropical areas
Shigella sonnei (subgroup D)
MC and mildest form in U.S. (about 85% of cases)
- Ornithine/ONPG (+), indol neg
Dx: TSI=K/A-, LIA=K/A-, URE=Neg, Non-motile, anaerogenic, lactose negative, LYS negative, Indol variable
- S sonnei is distinct (Ornithine & ONPG positive while indol always negative)
- Mannitol (+) for all except Sh. dysenteriae
- Ornithine negative for all except Sh. sonnei
- ONPG is (+) S. sonnei, negative S. flexneri
- colorless on XLD b/c no H2S produced
Serology: some spp have capsular or envelope Ags that inhibit agglutination of O antisera
- must heat to inactivate these Ags
- serotypes based on cell wall “O” antigens
S dysenteriaeae → Subgroup A = 10 serotypes
S flexneri → Subgroup B = 6 serotypes
S boydii → Subgroup C = 15 serotypes
S sonnei → Subgroup D = 1 serotype
Tx: fluoroquinolone-resistant strains available
- ciprofloxacin-resistant infx in gays
Cronobacter
~1/2 assoc c Enterobacter and Citrobacter
- Cronobacter sakazakii was previously known as Enterobacter sakazakii
- Most serious cases of C. sakazakii come from powdered infant formula contaminate with the bacterium (sequence Type 4)
Sx: Infants infected with C. sakazakii feed poorly, are irritable, jaundiced, grunt while breathing, unstable body temperature, and may lead to meningitis, necrotizing enterocolitis and sepsis
Dx: oxidase negative, catalase positive, facultatively anaerobic, peritrichously flagellated Gram negative rods, nitrate and citrate positive
- usually VP positive, Negative for H2S and urea hydrolysis
TSI =A/AG- LIA = K/A- URE neg, ONPG+, VP+, Motility pos
- Lys neg, ARG & ORN pos, lactose Pos, Cit Pos,
- Yellow pigmented
Cronobacter species
1. Cronobacter sakazakii
2. Cronobacter malonaticus
3. Cronobacter turicensis
4. Cronobacter muytjensii
5. Cronobacter dubliensis (three subspecies)
6. Cronobacter condimenti
Px: invasive infection of infants results in high case fatality rates of 40-80%
- MC in adults, but most serious infection in infants
Salmonella

Rose spots, S typhi


Salmonella spp

Salmonella spp on API20E

Shigella spp
Vibrionaceae
Gram negative asporpgenous rods, faculatatively anaerobic, glucose fermenters, oxidase positive, polarly flagellated, inhibited by vibriostatic
agent O129, nitrate positive
Spread via contaminated food and water
- involved in large epidemics or pandemics
- last epidemic 1991 South America still continues (V. cholerae O1, serotype Inaba, biotype El Tor)
Genera
1. Vibrio
2. Aeromonas
3. Plesiomonas
4. Photobacterium
- New family Aeromonadaceae
- May include two new genera: Listonella & Shewanella
Non-halophilic vibrio flavors
Vibrio cholerae serovar O:1
"classical" and El Tor biotypes
- have toxin c A (active) and B (binding) subunits
- 3 serotypes; Inaba, Ogawa, Hikojima
Sx: Asiatic cholera, massive loss of fluid & electrolytes causes dehydration
Specialized Media
1) TGA: taurocholate-gelatin agar
2) TCBS: thiosulfate-citrate-bile salts agar
3) TTGA: tellurite-taurocholate-gelatin agar
- use feces or do rectal swab, can be enriched c alkaline peptones, may also use Cary-Blair media
Serology: 139 serogroups based on O antigens
- have common H antigen
Serogroup O:1 subtypes
1) Ogawa (A, B)
2) Inaba (A, C)
3) Hikojima (A, B, C)
- Positive Reactions: Oxidase, Indol, Citrate, Sucrose, ONPG, Motility
- Negative Reactions: Urea, Esculin, Gelatin, Lactose
- TSI = A/A-, LIA = K/K-
- Decarboxylases: Lysine +, Arginine-, Ornithine+
- String test positive, Inhibited by vibriostatic agent O/129
Tx: Oral rehydration salts to replace fluid & electrolyte loss
- w/o rehydration, up to 50% of cases may be fatal
- Azithromycin may be used in severe cases
Vibrio cholerae O139 Bengal
Similar to Vibrio cholerae O:1 biotype El Tor
- Transmitted by contaminated surface water
- survives better in envt than Vibrio cholerae O1
Sx: identical to classical asiatic cholera
- India, Bangladesh, S.E. Asia
- Immunity to V. cholera O:1 offers no or little protection from infection with O139 Bengal strain
Dx: same isolation as for Vibrio cholerae O:1
- Not detectable using O:1 antisera based tests
- agglutinates with its specific antisera
- May cross react with antisera to O22
Vibrio cholerae non O:1
Biochemically identical to Vibrio cholerae O1
- Does not agglutinate in O1 antisera
- Produces an enterotoxin different from cholera toxin
Sx: Isolated cases of gastroenteritis, bacteremia
Vibrio mimicus
Biochemically very similar to Vibrio cholerae
- Gastroenteritis
Halophilic vibrios
Infection usually limited to gastroenteritis
1. Vibrio fluvialis
2. Vibrio furnissii
3. Vibrio hollisae
4. Vibrio parahaemolyticus
- Major cause of gastroenteritis in Japan
- vibrio parahemolyticus grows on TCBS agar and is transmitted by seafood (oysters)
Extraintestinal
1. Vibrio alginolyticus
- Ear infx, conjunctivitis, wound infx, bacteremia
2. Vibrio carchariae (V. harveyi)
- Pathogen of sharks, human wound infections
3. Vibrio cincinnatiensis
- Meningitis
4. Vibrio damsela
- Wound infections
5. Vibrio metschnikovii
- Bacteremia, peritonitis, gastroenteritis
6. Vibrio vulnificus
Small, curved gram neg rod; OX+, motile, lactose fermenter, grows on TCBS and needs 6% NaCl
- acquired c infected seawater, MCC death from vibrio in USA; can be acquired by eating raw oysters
- virulence c capsule, elastolytic protease, collagenase and cytolysins
- formerly "Lactose pos halophilic Vibrios"; cause bad septicemia and assoc c preexistent liver dz
Sx: Septicemia, fasciitis, myonecrosis, gastroenteritis
- septecemia esp quick and lethal in those c liver dz
Tx: susceptible to most abx
Aeromonas
1. Aeromonas hydrophila 4. Aeromonas janaei
2. Aeromonas caviae 5. Aeromonas media
3. Aeromonas veronii 6. Aeromonas eucrenophila
- biogroups sobria and veronii in sobria
Dx: Growth requirements & Cultural Characteristics
- Most strains grow on enteric agars as lactose fermenters
- AMP/blood agar, alkaline peptone water, CIN agar
- DNase+, ORN-, VP+, esculin+, IND+, Suc+, β-hemolytic, gas from glucose
Sx:. Gastroenteritis
- extraintestinal Infections
- Cellulitis, wound infx, septicemia
- infx assoc c medicinal leeches
Plesiomonas shigelloides
Dx: DNase-, ORN+, VP-, esculin-, IND+, Suc-, non-hemolytic, no gas from glucose
Sx: Gastroenteritis and extraintestinal infx
Chromobacterium
1. Chromobacterium violaceum
2. Chromobacterium fluviatile
Sx: Rarely causes infx in humans
- Skin abscesses or overwhelming septicemia
- Also pulmonary, liver, subcutaneous abcesses, eye
- Most cases of septicemia are fatal
Dx: Pus, blood, autopsy specimens
- Grows on most ordinary lab media containing tryptophane (BAP, Choc)
- Grows aerobically & anaerobically at 30-35°C but growth enhanced at 25°
- Colonies have an intense violet pigment
- Glucose fermenter, usually oxidase positive
● Positive for ARG, negative for LYS and ORN
● Catalase positive, growth on Mac, no growth at 4°C
● Nitrate positive, ONPG negative, CHO fermentations done in Andrades

Vibrio cholerae

positive string test c 0.5% sodium deoxycholate

Chromobacterium violaceum on DNase agar
Yersinia enterocolitica
Gram neg rod, urease (+), motile, no capsule
Caused by ingestion of contaminated food & water
- assoc c animal poo (swine, dogs, milk, rodent)
- Inc prevalence in colder areas
- grow on MacConkey incubated @28C, Cefsulodin-Irgasan novobiocin agar
- pathogenicity assoc c pYV virulence plasmid
- has been assoc c transfusion rxns
Sx: enteritis (kiddos), non-bloody diarrhea, abd pain
- Abd pain can mimic appendicitis (mesenteric
lymphadenitis)
- can cause bacteremia, peritonitis, visceral abcesses
- worse in immunocompromised patients c septicemia (mortality 50%)
Dx: temperature dependent motility, URE+, ORN+
- TSI=K/A- or A/A- (orange-yellow slant)
- grows on most plating media even at low temps
API20E: (+) Glu, Man, Sor, Sac, Amy, Ara
- Ino, Rha, Mel
Cefsulodin, Irgasan, Novobiocin (CIN) agar - "Bulls eye" colonies
-- Cellobiose, Arginine, Lysine (CAL) agar specific for Yersinia
-- cold enrichment questionable, incubate @ room temp
- Pretreatment with KOH may increase recovery
- 4 DNA homology groups (group I. contains Y. enterocolitica which is a primary pathogen)
Tx: Mostly mild and self-limiting
Yersinia pestis
Cause of bubonic plague (Black Death)
- Bubonic form MC
- Pneumonic form most dangerous form (90% fatality)vs Bubonic form (75% fatality)
- septicemia can cause meningitis & affect various organs
- transmitted via bite of infected rodent fleas, or through Pneumonic form (most dangerous, 90% fatal)
- epidemics in Central / South America and Asia
- endemic in San Bernardino Mountains (ground squirrels)
- Justinian plague (500 AD), Black death (1300 AD). Modern pandemic (1855-present)
Sx: Many antigenic & toxic factors in lymphatics
- Buboes: dramatic lymph node involvement
Dx: very unreactive, like Shigella, non-motile
- Wayson's Stain: bipolar, safety-pin morphology
- Gram Stain: plump Gram negative bacillus
- Stalactite pattern growth in broth
- Three biotypes based on melibiose, glycerine, and nitrate rxns
- TSI = K/A-, LIA = K/A-
- Negative Rxns: Indol, citrate, urease, motility, decarboxylases
- (+) blood cultures in all cases of septicemic plague and 4/5 cases of bubonic plague
-- "beaten copper" colonies on plating media
Tx: streptomycin, gentamicin, tetracyclines
Yersinia pseudotuberculosis
Found in birds, rodents, farm animals
- MC in Europe (not too much in USA)
- ingested in contaminated food & water
Dx: Temperature-dependent motility, URE+, esculin+
- TSI = A/A- or K/A-
Sx: enteritis to slowly progressing sepsis
- can mimic acute appendicitis (mesenteric lymphadenitis )
- rapidly fatal fulminating septicemia in patients with underlying liver disease
Other Yersinia species
1. Yersinia frederiksenii 5. Yersinia aldovae
2. Yersinia intermedia 6. Yersinia bercovieri
3. Yersinia kristensenii 7. Yersinia ruckeri
4. Yersinia rohdei 8. Yersinia mollaretii
VOGES-PROSKAUER POSITIVE ENTERICS
Klebsiella pneumoniae
OX neg, , lactose-fermenting gram neg bacillus
- MC KPC carbapenemase-making pathogen
- strains are evolving that are resistent to all penicillins, cephalosporins, carbapenems, aztrenam
- freq cause of hosp acqd infx
- causes destruction of alveolar spaces, cavities, blood-tinged sputum, UTIs and sepsis
Carbapenem-resistant Klebsiella pneumonia (CRKP) associated with high morbidity & mortality
- seen in pts c prolonged hospitalization / critically ill exposed to invasive devices (ventilators or central venous catheters)
Sx: red currant jelly sputum, aspiration pneumonia, septicemia, nosocom UTI, meningitis, lung abscesses
- assoc c alcoholics, lung abscesses, diabetics
- other hosp acqd infx: A baumanii, P aeruginosa
Dx: Automated susceptibility systems can give misleading results
- isolates make carbapenemase - confers resistance to all beta- lactam antimicrobials and are frequently resistant to most other agents as well
- carbapenemases divided into 3 classes (A, B, and D) and known as extended spectrum beta lactamases (ESBLs)
- transmission via plasmids, class A are KPC and found c Kleb pneumoniae, Serratia and Enterobactericiae
- class B are metallo-B-lactamases like IMP, VIM, and SPM make by P aeruginosa, Acinetobacter, S maltophilia and Enterobactericiae
- test for KPC-mediated resistance c Hodge (clover leaf) test
- large mucoid colonies on enteric plating media
- 72 Capsular types (Quellung Rxn); very biochemically reactive
- Ferments most carbohydrates
- Positive Rxns: ONPG, Lysine, Urease, and Citrate
- Negative Rxns: Motility, Arginine & Ornithine,
- TSI = A/AG, LIA = K/K
- Voges-Proskauer (+) - (also Enterobacter, Hafnia, Serratia)
Tx: options limited
Px: Potentially deadly infections in immunosuppressed patients (inc risk dissemination)
Klebsiella oxytoca
Similar to Kl. Pneumoniae but is Indol positive or Indol and Gelatin positive
Klebsiella ozaenae
Variable biochemical reactions (difficult to id)
- etiologic agent of ozaena an atrophic disease of nasal mucosa (Also; chronic disease of respiratory tract)
Klebsiella rhinoscleromatis
in India, N.Africa, S.E. Europe, Central & South America, but rare in the U.S.
- causes chronic, destructive, granulomatous process in the nasopharynx
- Found exclusively in patients with rhinoscleroma
Klebsiella granulomatis
- formerly Calymmatobacterium granulomatis
- fastidious encapsulated bacillus in macrophages
- causes granuloma inguinale (Donovanosis), STD
- see painless lesions on genitalia and surrounding areas that becomes a beefy red ulcer
- rare in the USA, more prevalent in Caribbean, Brazil, parts of Africa, SE Asia, and in aboriginals in Australia
- cannot be cultured in conventional agar media
- dx by observation of “Donovan Bodies” in tissue smears or biopsy specimens stained by Giemsa and Wrights stains
Enterobacter
MC are Enterobacter aerogenes / cloacae (separated using Lysine / Arginine decarboxylase tests)
- E aerogenes- Lys (+), Arg neg
- E cloacae - Lys neg, Arg (+)
- opportunists, (soil, water, dairy products, intestinal tract, etc.)
Sx: UTI, nosocomial infections
Enterobacter gergoviae
- urease positive, and multi-drug resistant
- resistant UTI, blood isolates, wounds, nasopharynx
Enterobacter sakazakii
Yellow pigmented, similar to E. cloacae but is sorbitol negative
- causes neonatal meningitis
Hafnia alvei
- TSI = K/AG, LIA = K/K
Serratia marcescens / Serratia liquefaciens
S. Marcescens has a pink pigment (like the cherry!)
- Dnase & Gelatin positive
- Serratia rubidea has a red pigment
- Serratia odorifera has a strong odor
Misc. VP Positive Enterics
1. Rahnella
2. Ewingella
3. Pantoea agglomerans
PHENYLALANINE DEAMINASE POSITIVE ENTERICS
Morganella
- TSI = K/A-, LIA = R/A, Urease positive
1. Morganella morganii
2. Morganella morganii biogroup 1
Proteus spp.
Proteus mirabilis
UTI, swarming on culture media, H2S positive, Urease positive, ornithine positive
*** MOP = Mirabilis Orn Pos ***
- lactose negative, sucrose & indol negative
- TSI = K/A+, LIA = R/A
Proteus vulgaris
UTI, swarming, H2S positive, Urease positive, lactose negative, sucrose & indol positive,
*** VIP = Vulgaris Ind Pos ***
- ornithine negative
- TSI = K/A+, LIA = R/A
-has chromosomal B-lactamase, makes it resistant
*** VIP = Vulgaris Indole Positive **
*** MOP = Mobilis Orn Positive ***
Pr. mirabilis & Pr. vulgaris implicated in bacteremia, intraabdominal wound infections and catheter assoc UTI in elderly
- Pr.mirabilis responds more readily to antimicrobial therapy than other Proteus spp.
- TSI = K/A+, LIA = R/A
Proteus penneri
may also swarm (blood, urine, feces, etc.)
Proteus myxofaciens
Providencia spp.
- TSI = K/A, LIA = R/A
- UTI and other infections especially in debilitated hosts
1. Providencia rettgeri
2. Providencia stuartii
3. Providencia alcalifaciens
4. Providencia rustigianii
Miscellaneous Phenylalanine Positive Enterics
1. Rahnella aquatilis
2. Tatumella ptyseos
Y enterocolitica on CIN agar


Y pestis - Wayson's stain

Y pestis - buboes


Mucoid colonies of K pneumonia

K rhinoscleromatis

K granulomatis - Donovan bodies

K granulomatis - granuloma inguinale
Donovan bodies

Serratia marcescens


Proteus spp swarming
Campylobacter and Helicobacter
History
1909: Vibrio fetus associated with bovine abortion
1947: First human case reported
1957: King reported that Campylobacter jejuni was associated with diarrhea
1972: Dekeyser reported Campylobacter isolations from feces of patients with diarrhea
1977: Skirrow reported on a new culture technique using a selective media
1984: Isolation of Campylobacter pyloridis from human gastric tissue
1991: Helicobacter pylori associated with peptic ulcer disease and gastric carcinoma
- Short, thin, curved rods that stain poorly: must modify Gram stain procedure for best results
- Characteristically: Spiral shapes, "S" shapes, "Gull wings", and curved rods
1. Atmospheric Requirements: Microaerophilic
2. Temperature: Grows well at 42○C
3. Selective Media:
Campy BAP (Skirrow's, Blazers's, Butzler's, etc.)
Campy Thio
4. Transport Media:
Cary-Blair
Campy Thio
Biochemistry (C jejuni and C coli)
- Oxidase positive (may be weak)
- Catalase positive
- Growth at 42○C (not at 25○C)
- Sensitive to Nalidixic Acid (30μg disk)
- Resistant to Cephalothin (30μg disk)
- Hydrolyzes Indoxyl Acetate
Campylobacter jejuni enteritis
Curved, gull-winged shape gram neg bacillus that grows in microaerophilic conditions and causes (undercooked) food-borne dz (the shits), sometimes bloody diarrhea c mucosal ulceration
- normal enteric pathogen of cattle, dogs, birds
- Humans with diarrhea: 3-11% recovery rate
- Healthy individuals: <1% recovery rate
- kids may be reservoirs, spread P2P, or ingestion
- highest incidence in summer
- Occasional simultaneous isolation from blood and stool
- Development of specific IgG during course of infection; incubation period 2-10 days
Sx: Abd pain (9/10), diarrhea (almost all), chills / fever (9/10),
- self-limiting, lasting two to seven days
- 1/4 relapse
- peaks for 2-3 days
- may be responsible for Guillain-Barre syndrome (esp type O:19) and enteropathic artritis
Tx: Erythromycin, maybe others
Dx: Serology: very complex
- hippurate positivity distinguishes Campy jejuni from other Campylobacter spp
- Immunofluorescence and Latex Agglutination, ELISA, Indirect Hemagglutination, Phage typing
Helicobacter pylori
Gram neg spiral bacillus
Helicobacter pylori, heilmannii, cinaedi, westmaedii,
fennelliae, canadensis, canis, rappini
- H. cinaedi and H. fennelliae isolated from rectal swabs of male homosexuals (enteritis, proctitis, blood isolates)
- H. pylori : gastritis is MC GI infx of humans
- H. pylori commonly in Peptic Ulcer Disease, always in association with active chronic gastritis
- H. pylori may also play a role in gastric carcinoma
Dx: specimens will be biopsies
- Media include CHOC, MTM, Egg Yolk Emulsion Agar, and Campylobacter selective medium
- Belo-Horizonte medium specifically for H. pylori
- Plating media is incubated under microaerophilic conditions, at 37○C, under high humidity, and held for seven days
Biochemistry: Urease is positive, often very rapidly (certain rapid tests are based on this characteristic)
- Oxidase and Catalase positive, Alkaline phosphatase positive
- Hippurate negative, H2S negative, Indoxyl Acetate negative
- Nalidixic Acid = R, Cephalothin = S
- serological tests also available
Direct Detection
- Warthin-Starry or other silver stain / Giemsa stain for biopsy specimens (also Gram stains on squash preps)
- Use of urease broth or commercial urease agar kits
- Urea breath test: patient ingests 13
bicarbonate (exhaled as CO2)
- Also stool antigen tests and PCR
Tx: Metronidazole and bismuth heal ulcers
- Amoxocillin + bismuth very effective
- tx can lead to inc gastric acid production from atrophic gastritis reversal, causing unmasking of GERD
Arcobacter
1. Arcobacter cryaerophilus 3. Arcobacter skirrowii
2. Arcobacter butzleri 4. Arcobacter nitrofigilis
- Arcobacter cryaerophilus and Arcobacter butzleri known to cause gastroenteritis in humans. Septicemia has also been described for these species.
- Arcobacter skirrowii has only been found in animals
- Arcobacter nitrofigilis is associated with plant roots


Spirochetes
*** BLT ***
Borrelia, Leptospira, Treponema
- brachyspira (aalborgi and pilosicoli) maybe too
Spiral shape, at least one complete turn, usually many, anaerobic, form false brush border in colon
- Gram negative cell wall/membrane
- Cell wall is Not Rigid
- Motile by axial fibrils
- Insertion disks (plates where fibrils attach to cell)
a) Darkfield Microscopy
b) Special Stains
Treponema pallidum
Causes syphilis
MC in 20-29 yr. olds, Over 100,000 cases annually in U.S., transmitted by sexual contact , transplacental (congenital syphilis), most infectious early in the disease (especially when chancre is present)
Primary Stage:
- Systemic disease from the onset
- A painless papule (hard chancre) develops at the site of entry
- Chancre- external genitalia most frequent site, also mouth, cervix, breast, perianal area
- Chancre is highly variable, heals spontaneously in 3 to 6 weeks
Secondary Stage:
Presents 6 weeks to months after initial contact.
- Lesions appear on the skin, particularly mucous membranes, also palms and soles of the feet
- All secondary lesions are highly infectious (lips, mouth, pharynx, vulva, glans penis...)
- Rashes in this phase called Syphilitic Dermatitis
- Condyloma lata - papulo-pustular lesions
- Systemic symptoms; fever pharyngitis, headache, rash on trunk and limbs, malaise, "Great Imitator"
- Symptoms subside and patient enters the latent period
- During latent period, diagnosis can only be made serologically
Tertiary Stage:
- AKA "late syphilis", develops in 1/3
- May occur 5 to 40 years after initial infection
- Slow progressive inflammatory disease which can affect any organ of the body (cardiovascular system & CNS affected)
- Dementia, seizures, blindness, heart problems, etc.
- Tertiary lesions; GUMMA...soft "gummy" chronic granulomas (rubbery, few organisms are present), tabes dorsalis (neurosyphilis), aortitis
- Argyll Robertson pupil (prostitute's pupil - accommodates but doesn't react)
Congenital Syphilis:
If not stillborn, many severe and often mutilating complications are seen in the infected infant
- saber shins, saddle nose, CN VIII deafness, Hutchinson teeth, frontal bossing, snuffles (bloody nasal secretions)
Culture: Wild strain T. pallidum cannot be cultured
Nichol's Strain - virulent, grown in rabbit testicles
Reiter's Strain - avirulent, can be grown in complex media
- Sensitive to drying, temp > 42C, and small doses of penicillin
- Microaerophilic
- Microorganisms may remain viable for 24hrs. in blood at 4C
- Little is known of antigenic properties
Dx:
Direct exam: Useful for primary / secondary stages
- Darkfield exam; direct examination of serous exudates from abraded lesions
- Special stains; silver impregnation stain, fluorescent Ab stain
Serology: Most useful in diagnosis of Syphilis, many tests but all are of two general types
Non-Treponemal Tests:
- Use a non-treponemal antigen (Cardiolipin)
- "Reagin" is Ab to Cardiolipin
1) VDRL Test - flocculation test that uses cardiolipin, cholesterol and lecithin
2) RPR Test - cardiolipin antigen modified c choline chloride; cant be done on CSF
Treponemal Tests:
- Use a treponemal antigen
1) Fluorescent Treponemal Antibody (FTA)-Absorbed (Reiter strain as Sorbent)
2) MHA-TP (Reiter strain)
3) TPI (Nichol's strain)
Tx: Benzathine penicillin (more for later stages)
Treponema pallidum spp pertenue
Causes Yaws, a nonvenereal treponemal disease
- called Frambresia if disseminated
- Restricted to rural populations of tropical countries
- Endemic in central Africa, India, South America, S.E. Asia
- Primary, Secondary, and Tertiary stages
- Destructive lesions on skin and bone
- Chronic disease, may last for many years
- Treatment → benzathine penicillin
- Antibodies to T. pertenue are indistinguishable from those of T. pallidum
Treponema carateum
- Causes pinta
- Present in Central and South America
- Dyschromic skin lesions that eventually become depigmented
- Spread by contact with infected skin lesions
- Chronic disease, may last for many years
- Antibodies from patients with pinta cross-react with antigens of T. pallidum
Treponema pallidum spp endemicum
- Causes endemic syphilis or Bejel
- Endemic in Aftica, the Middle East, India, Asia
- Non-venereal milder form of Syphilis occurring in childhood
- Found solely in less-developed tropical and subtropical areas
- Chronic disease, may last for many years if not treated
- Treatment → benzathine penicillin
- Antibodies cross react with T. pallidum
Spirochetes in a false brush border


Borrelia
Treponema
Leptospira

Secondary syphilis


Darkfield exam

Yaws


Pinta

Bejel
Borrelia
Borrelia recurrentis & Borrelia hermsii epidemic
- largest of the pathogenic spirochetes, coarse
irregular coils
- stained c ordinary dyes
- arthropod vector (ornithodoros hermsii soft-bodied tick)
- 20 species, 12 cause relapsing fever
Sx: 3d to 2 wk incubation period, then sudden chills, fever, headache, tachycardia, muscle pain,
vomiting, diarrhea
- relapses common; a single relapse with louse-borne relapsing fever, up to ten with tick-borne relapsing fever
- can change antigenically
- found in the blood during febrile periods
- few orgs present during afebrile periods
Dx:
Direct examination; demonstration of organisms in peripheral blood of febrile patients
- Blood will be positive with darkfield exam (7/10)
- Can stain with Giemsa or Wright's stain
- Borrelia are microaerophilic and have complex growth requirements
- culture c Kelly's medium (Barbour-Stoenner-Kelley media)
Tx: Tetracycline or Erythromycin ( also Penicillin, Chloramphenicol)
- Jarisch-Herxheimer reaction → common in louse-borne relapsing fever
Borrelia recurrentis
Transmitted P2P c a body louse (Pediculus humanus ssp. humanus) vector
- reservoir is infected lice
- at risk crowding, poverty, cold climate
Found worldwide, endemic in Ethiopia
Dx: thick peripheral blood smear
Borrelia hermsii
Transmitted by animal to man via soft-bodied ticks (Ornithodoros hermsii ) vector
- reservoir is infected ticks and rodents
- at risk if camping, hunting, warmer weather
- found endemic in western U.S.
Borrelia burgdorferi
Causes Lyme disease in North & South America, Europe, Asia, Africa, and Australia by hard-shelled ticks, Ixodes spp. vectors
- MC tick-borne disease in U.S.
- co-infx c Bebesiosis and/or Flavivirus common
Sx: fever, heacache, stiff neck, nausea, vomiting,
myalgias, fatigue
Stage 1: erythema chronicum migrans (characteristic bulls-eye lesion) in 1/3
- Stage 2: untreated pts get cardiac (AV blocks), neurologic (Bells palsy), or arthritic complications weeks to months after lesion appears
- arthritis develops in large joints (knee especially)
Dx: based primarily on clinical presentation
- Isolation attempts non-productive, serologic testing best method (IFA, ELISA, also Latex Agglutination)
- Serologic testing done only when clinical evidence suggests a diagnosis of Lyme disease
- Western immunoblot test done to verify positive ELISA or IFA
- May give false positive FTA-Abs test
Tx: Doxycycline most effective
- Penicillin and Erythromycin also effective especially if given early in disease course
- Penicillin in high doses to treat arthritic and neurologic complications
Borrelia miyamotoi
Found in 2011 in Russian pts c relapsing fever
- no erythema chronicum migrans
- non-reactive to B bourgdorferi Ab
Leptospira
Causes leptospirosis, Infectious Jaundice, Weil's Disease, Canicola Fever, etc.
- animal dz transmitted accidentally to man in piss
- can be cultured on artificial media containing animal
serum. (Fletcher's Medium)
- only 2 sp recognized, Leptospira interrogans and
Leptospira biflexa (L. biflexa are nonpathogenic & free-living)
- arranged into serovars by antigenic composition
- Leptospira interrogans serovars are arranged into serogroups for diagnostic convenience only
- in U.S. find icterohaemorrhagiae, canicola,
pomona, grippotyphosa, and hardjo
Leptospirosis
Spread by contact with urine from infected animals, giant tree rats
- Occupational disease
- enters abraded skin and exposed mucous membranes
Sx: chills. fever, headache, G.I. symptoms, muscular pain, conjunctival infection (photophobia)
- predilection to colonize kidneys
- Can also involve the brain (meninges), lungs, and liver
- Hemorrhaging or jaundice = poor prognosis
Dx
Direct examination of blood and CSF (first week) and urine after the first week
- culture c Fletcher's medium (rabbit serum or special Leptospira enrichments)
- Inoculate with blood or spinal fluid during first week of illness
- Inoculate media with urine after first week
- Incubate at 30○C or room temperature, in an aerobic incubator
- look for presence of motile tightly coiled spirochetes with hooked ends (usually within 2-14 days, may require up to six weeks)
- Microscopic agglutination and absorption tests are available in selected reference laboratories for definitive identification
Tx: Penicillin or Streptomycin if given early
Spirillaceae
Helically curved rods c rigid Gram negative cell wall and cell membrane structure
- typical bacterial flagella motility
- biochemically inert
Spirillum minor
- has not been cultured in artificial media
- Short thick organism with tapering ends (0.2 - 0.5μm x 3-5μm)
- Gram negative but stains poorly
Sx: Rat Bite Fever - spread by wild infected rat, enters lymphatic system
- Haverhill Fever is one form of Rat Bite Fever caused by Streptobacillus moniliformis **
- Sodoku Fever is another form of "Rat bite fever" that is caused by Spirillum minor
- Sodoku Fever is a bacteremic dz of wild rats that is transmitted to animals and man by infected rat bite
- Clinical course → wound heals promptly after bite, 5-14 days later swelling occurs and later develops into a chancre-like ulcer, then enter the lymphatics
- sx: malaise, headache, fever, chills
Dx:based on demonstration of organisms in animals
inoculated with patient's blood or lesion exudates
- Dark-field examination of material from lesions
Tx: Penicillin
- Streptomycin also
Borrelia EM


Erythema chronicum migrans

Leptospira

Giant tree rat

Brucella
Very slow grower, gram + cocci; 6 spp in man that can cause brucellosis or undulant fever:
Bru. melitensis (sheep and goats, Mediterr, most virulent and prevalent!); canis (dogs, cosmopolitan), abortus (cattle, worldwide), ovis (sheep), suis (pigs, S America), neotomae (desert wood rat), in California and Texas in Hispanics
- Chronic, relapsing febrile illness c weight loss, loss of appetite, night sweats, stinky sweat!
- goto reticuloendothelial cells after entering body
- Occupational disease, transmitted by direct contact or by drinking raw milk or aerosol (lab)
- MC in Cali and Texas
- potential in bioterrorism! (needs lab precautions)
Dx: Blood cultures (poor sens): drawn during acute or febrile periods, do NOT perofrm catalase (can aerosolize organism)
- Occasionally recovered from bone marrow, lymph nodes, and other tissues (usually during chronic period)
- Does not grow in peptone
- Need tryptone or trypticase + liver infusion, calf serum, or yeast
- Slow growing, colonies visible in 3 - 7 days
- Non-selective media: Brucella agar (tryptone + yeast)
- Selective media: Brucella agar + antibiotics or dyes
- Incubate at 35 C, in 5-10% CO2, moist atmosphere
- Colonial Morphology: pinpoint, smooth, glistening colonies, no hemolysis
Histo: Small Gram negative (poor gram stain) rods to coccobacilli, no spores, singly or in pairs
- Modify Gram stain procedure by leaving counterstain on 2-3 min.
Biochemical
Catalase, Oxidase, Nitrate positive
- Strong Positive urease test: semi-quantitative test
- H2S production using lead acetate strips (B. abortus is positive)
- CO2 requirement for growth (some strains of B. abortus)
- Growth in presence of certain dyes (basic fuchsin, thionine, etc.)
Serology:
- Slide agglutination test
- Tube agglutination test: serial dilutions of patients serum
-- End point titer = highest dilution exhibiting 50% agglutination
-- Rising titers diagnostic
Tx: close contacts need 3 wks prophylaxis c doxycycline and rifampin
Bordetella
1. Bordetella pertussis 5. Bordetella hinzii
2. Bordetella parapertussis 6. Bordetella holmsii
3. Bordetella bronchiseptica 7. Bordetella trematum
4. Bordetella avium 8. Bordetella petrii
Bordetella pertussis
Small gram neg coccobacillus, makes adhesins and pertussis toxin
Sx
- Humans only, most dangerous in infants, no true carriers, highly contagious (by coughing)
- Disease = pertussis or whooping cough, also a milder respiratory tract infection
- Incubation period = 7-10 days
- attaches to respiratory epithelial cells and makes a cytotoxin that paralyzed cilia
- ADP ribosylating A-B toxin increases cAMP through Gai inhibition (turns the "off" off), causing whoopin cough
Common childhood disease before 1950's when DPT introduced
- DPT vaccine induced encephalopathy England 1973
- caused a hugh outbreak in California in 2010
Three stages or phases
a) Catarrhal phase; first 1-2 wks., "cold-like" symptoms
b) Paroxysmal phase; coughing stage, may last several weeks
c) Convalescent phase; may last several weeks more, pneumonia apparent asymptomatic "carriers" at this stage
Specimen collection and processing
- Nose/throat swabs or aspirates
- Two swabs, one for immediate inoculation of plating media, the other for direct smears (DFA & Gram Stain)
- rtPCR used increasingly to dx (better sensitivity)
Direct Examination (DFA)
Two smears prepared and stained with fluorescein-labeled anti- pertussis rabbit serum and anti-parapertussis antisera
- DFA performs well as a screening test
Growth Recs
- Bordet-Gengou (potato) medium or Regan-Lowe (charcoal) medium
*** BORDET for BORDETella ****
- Inoculate immediately and incubate in moist atmosphere at 35○C
with or w/o CO2, for up to seven days
- Tiny, smooth, transparent colonies in 3-5 days
- Small, Gram negative coccobacilli (take counterstain poorly)
Tx: erythromycin given to all household and close contacts
- DTap series should be given to all those under 7 yrs, at 2,4 and 6 mo, 15-18 mo, and 4-6 years of age
Bordetella parapertussis
Found only in humans, chronic carriers
- Causes milder form of whooping cough
Bordetella bronchiseptica
- Common cause of bronchopneumonia in animals
- Rarely isolated from humans, wounds & abcesses
Pertussis Vaccines
- Whole-cell vaccines manufactured in many countries but cause adverse reactions and lack long-term immunity
- New acellular vaccines c booster doses in older children and adults now used
- Tdap if 10 yo or older (adults)
B melitensis (A) regular gram stain (B) 2-min safranin




Media for pertussis and parapertussis




Francisella tularensis
Intracellular, small gram-neg coccobacillus, OX neg, no MAC grow
- highly infectious, - must report to public health, need special lab precaution, causes Tularemia, mostly a rodent dz
- spread by arthropod vectors, ticks / deer flies
- also direct contact with infected animal tissue, improperly cooked meat, contaminated water, inhalation (penetrates small breaks in skin)
- need to use Biosafety Level 2 or 3 in lab
- not transmitted P2P
- Prevalence higher in summer months
- Persons engaged in agriculture, forestry, rabbit hunting
- classified as class A bioterrorism agent
Sx: "Flu-like," papules, ulcers, lymphadenitis (less commonly pneumonic or gastro-intestinal form)
Dx: PCR (serum?)
- usually isolated from lesions or lymph nodes, sputum or nasopharyngeal washings,rarely blood
- Direct exam on exudates, DFA reagents available
- can be serology, also PCR assay
To culture, needs cystine or cysteine Glucose Cystine Agar (grows on sheep blood)
- Small moist colonies, slightly α-hemolytic
- Incubate at 35○C, does not require CO2
- May take 3 weeks to grow
- Media can be supplemented with antibiotics
- Coccoid, Gram negative rods that stain poorly, bipolar staining, OX neg, no growth on MAC
- Direct Gram stains of exudate are usually negative
Tx: streptomycin
Px: Poor
Afipia
named after Armed Forces Institute of Pathology
1. A. felis 4. Genospecies 1
2. A. clevelandensis 5. Genospecies 2
3. A. broomeae 6. Genospecies 3
causes Cat Scratch Disease (CSD) in kiddos
- Infection is asymptomatic or with a painful lymphadenitis
- papule forms at site, then regional lymph node enlargement, also fever, general malaise, fatigue, headache, sore throat, rash
- May disseminate to liver, spleen, encephalitis
- Only A. felis is associated with CSD
Dx: LN / skin biopsies for Warthin-Starry silver stain
- Lymph cultures usually sterile or may yield difficult to grow cell wall defective variants of A. felis
- Skin lesions, conjunctival lesions, serum are also suitable
- For other species, respiratory secretions, wound material, normally sterile fluids
Culture: difficult, cell wall defective forms grow in BHI
biphasic media
- CYE for Legionella is an excellent growth medium
- A. felis is a pleomorphic, Gram negative rod with bulbous ends
- C.W.-defective forms - thin delicate filaments, branching & curved forms
Biochemistry
All strains motile by single polar, subpolar, or lateral flagellum
- A. felis is only species that is both catalase negative & nitrate positive
- A. clevelandensis: poor growth on Mac, catalase negative
- A. broomeae: weakly catalase positive, nitrate negative, xylose
fermented
Positive: Oxidase, Motility, Urease, Growth at 25,30,35○C
Negative: Indol, Gelatin, Esculin, Glucose, other carbohydrates
Bartonella
- Formerly a Rickettsiales
- Family Bartonellaceae includes 16 species, five of which cause disease in humans
- Most closely related to Brucella abortus & Agrobacterium Tumefaciens
- 1/10 cases of BCNE (confirm c serology)
Dx: Warthin-Stary technique on tissue bx
- isolation difficult on culture
-- specimens include aspirates & tissue (lymph nodes, spleen, cutaneous biopsies) and blood collected in an Isolator tube (lysis centrifugation)
- Organisms are fastidious and slow growing and grow best on chocolate agar under high humidity
- short Gram negative rods
- negative oxidase, catalase, urease, and nitrate
- Serologic tests such as the IFA can have cross-reactivity c Coxiella burnetii
Bartonella quintana and Trench Fever
- vector is human body louse
- see sudden onset of chills, headache, dizziness, postorbital pain, severe pain in legs & back, rash on chest, back, and abdomen
- Disease seen during WWI and WWII, with trench fever
- Reemerging pathogen among homeless in U.S. and European cities
Bartonella bacilliformis and Carrions’ Disease
- vector is Sandfly (Lutzomia spp.)
- seen in Andean Mountain regions of Peru and
Equador
- Acute disease → septicemia, malaise, fever, anemia, enlarged lymph nodes
- Chronic disease → bright red cutaneous nodules
Bacillary Epithelioid Angiomatosis & Peliosis Hepatitis
- Caused by Bartonella henselae
- Found primarily in domestic cats (reservoir)
- causes intraerythrocytic bacteremia in cats
- Persistent bacteremia, endocarditis, and cat-scratch disease (CSD)
- Peliosis hepatitis → gastrointestinal symptoms, fever, chills, enlarged liver & spleen
- Bacillary epithelioid angiomatosis & peliosis hepatitis seen most frequently in AIDS patients
- Cat-scratch disease also caused by B. clarridgeiae
- resolves in 1 mo when tx'd c tetracyc, macrolides
Streptobacillus moniliformis
only 1 spp in genus
- Pleomorphic Gram negative rods forming long,
curved,unbranching filaments (also coccoid forms & rods with swollen ends)
- Usual flora of URT of rats, mice, other rodents
- Causes rat-bite fever
- Acute onset of chills, fever, headache, severe joint pain
- Rash → seen in first few days, macropapular, petechial, or morbilliform, on palms & soles of feet
- Complications → endocarditis, septic arthritis, pneumonia
- Acquired by rat bite or through ingestion of contaminated milk
- Referred to as “Haverhill Fever” when acquired by ingestion
Dx: Culture requires media with added blood, ascetic fluid, or serum
- Must have moist environment, added CO2 , 37○C
- Colonies → small, non-hemolytic, colorless, glistening
- Mycoplasma type colonies (fried egg, L-forms)
- Grows a “fluff balls” or “bread crumbs” in broth
Rickettsiae
Includes families Rickettsia, Erlichia, Coxiella, Bartonella (above), Orientia, Anaplasma, Neorickettsia
- replicate intracellularly, but can survive for a little bit ouside cell, infect endothelial cells causing swelling that leads to disseminated mononuclear vasculitis c lots of monos and intravascular thrombi
- transmitted by arthropods
- serology only helpful in ~1/5 cases
Rocky Mountain Spotted Fever
aka New World Fever; caused by Rickettsia rickettsii, MC in SW USA, reservoir and vector is Dermacentor variabilis ticks on dogs and rabbits, rodents are also reservoirs, up to 2 week incubation
-Sx - abd pain, headache, fever, rash on wrists and ankles c several necrotic foci
- blacks c G6PD deficiency get rapidly fatal dz
Erlichiosis
In N America SE/SC/midatlantic states, mostly males in rural areas,caused by tick bite, can see the causative org on Wright-stain flood c intracellular vacuoles lookds like a morula or mulberries
-E sennetsu in Japan
- Sx- fever, TBCpenia, leukopenia, inc transaminase
Coxiella burnetti
Gram neg pleomorphic coccus c small cell variants (SCV, *Survivin Cell* in environment) and large cell variants (LCV, *Lacks Cell Viability* (dies) in envt) on EM, taken up by host's monos and causes Q fever, usually in farmers, veterinarians, spread by ticks, reservoir is cattle, birds, small rodents,
- acutely presents as flu-like sx c pneumonitis, hepatitis, tbcpenia (1/4); up to 1/50 die from myocarditis, granulomata seen in liver + BM and have fibrin-ring appearance, NO RASH
- chronic dz usually endocarditis, has no vegetations and blood cultures negtive, usually fatal if not tx'd, usually seen in immunosuppressed or c valve abnormality, see inflam c histiocytes and fibrin-rings on bx
- recrudescence can happen in preg and causes premature labor, up to death
-dx : serology, but lots of false negatives; can do PCR on valves but not blood
Enlarged LN in Tularemia

Carrion's disease

Hemorrhagic rash of rat-bite fever on palm

Streptobaccilus moniliformis

Erlichiosis

Actinobacillus
1. A. actinomycetemcomitans 6. A. capsulatus
2. A. ligniersii 7. A. rossii
3. A. equuli 8. A. pleuropneumoniae
4. A. suis 9. A. seminis
5. A. ureae
- shares characteristics c Pasturella and hemophilus
- A. ligniersii, A. equuli, A. suis are principally animal pathogens that only rarely cause human infection
- A. ureae is found in the respiratory tract, blood, CSF
- A. actinomycetemcomitans is part of the usual human oral flora and human infx is endogenous
- isolated with Actinomyces israelii in actinomycotic lesions
- Frequently associated with SBE, also brain abcesses, thyroid gland abcesses, oral abcesses, urinary tract infection
- Localized juvenile periodontitis
- spreads contiguously or hematogenously
Dx: Pus and blood usually submitted
- Actinobacillus spp. grow best on blood or chocolate agars (slowly), best if microaerophilic
- Two media, TSBV and H agar are designed to specifically recover
A. actinomycetemcomitans from periodontal and oral specimens
- Gram negative coccobacilli, singly, pairs, chaining, bipolar staining
- Colonies adhere to agar surface and may show a 4-6 pointed star structure on continued incubation
Biochemistry: Of the five species found in humans, all give A/A in TSI
- They are all negative for; decarboxylase tests, indol, citrate
- All are nitrate positive, all are non-motile
Kingella
2 species: Kingella kingae and K denitrificans
- Usual flora in upper respiratory tract of kiddos
- Straight rods or coccobacilli in pairs or short chains
Kingella kingae
- Opportunistic pathogen, esp in kiddos (day care)
- assoc c septic arthritis
- Blood, bone, corneal ulcer, joint fluid, nasopharynx, and skin lesions
Kingella denitrificans- rarely if ever pathogenic
Dx: All are oxidase positive, non-motile, ferment glucose, have special media (Tryptic soy agar)
Kingella kingae
Slow grower, weak β-haemolysis
- Colonial morphology varies, may pit the media or form fried-egg colonies
- CO2 enhances growth, Maltose fermented
Short plump rods with square ends
- growth on Thayer-Martin medium
Kingella denitrificans
Non-hemolytic colonies resembling those of K. kingae that grows on MTM medium, Oxidase +, Glucose +, Nitrate +, Catalase negative
Suttonella indologenes
Indol and sucrose positive (Kingella are negative)
- Associated rarely with eye infections
Legionella pneumophila
Gram neg rod responsible for Legionnaires dz (fever + pneumonia) and Pontiac fever (mild fever) - aerosol transmission from H20 (not P2P!) causing interstitial pneumonia
- seen best c silver stain (poor gram stainer)
- grows on charcoal yeast extract
***French legionnaire c charcoal campfire***
Dx: rapid ag test in urine
Tx: erythro or Z-pack
A. actinomycetemcommitans star


Legionella pneumophilia

"Legionnaire's Disease" was first used to describe an acute febrile respiratory illness that affected members and visitors attending the 58th annual convention of the Pennsylvania American Legion (July 1976).
- Faintly staining thin Gram negative bacilli
● Oxidase and catalase positive
● Gelatin positive (API 20E)
● Nitrate and urease negative
● Hippurate and β-lactamase positive
● Cell wall contains branched-chain fatty acids
● Will not grow on ordinary bacteriological media
Pontiac Fever
● Self-limited illness; fever, myalgia, malaise, headache
● High attack rate (95%), short incubation time (1-2 days)
● Few respiratory manifestations, no pneumonia
● Common source outbreaks
● First described during an outbreak in Pontiac Michigan during July & August of 1968
● Retrospective serologic studies indicated L. pneumophila was the etilogic agent
● No fatalities associated with Pontiac Fever
Legionnaire's Disease
Epidemiology: World-wide distribution, incidence higher in Summer months
● Sporatic cases as well as outbreaks
● Low attack rate (1-5%), more common in males
● Individuals over 50yrs. of age primarily affected; smoking is a predisposing factor
● Incubation period 2-10 days
● Association with soil, water, cooling towers
● Outbreaks in hospitals and hotels
● Immunosuppressed patients more susceptible
● Legionella-like pathogens infect and multiply in the cytoplasm amoeba
Sx
Non-remitting high fever (102-105 F), chills, rigors, headache, myalgia, abdominal pain, confusion, diarrhea, non-productive cough, hyponatremia
● Severe pleuritic pain, pneumonia in at least 90%
● Characteristic X-ray picture
● Shock is a poor prognostic sign
Dx:
● CYE = Charcoal Yeast Extract Agar
***French legionnaire c charcoal campfire***
● BCYE = buffered CYE
● Feeley-Gorman Agar
● Specimens for culture: set up on two agar plates, one of which is non-selective (done on ambient air)
● Specimens: bronchial brush, lung tissue, sputum, transtrachael aspirates, blood
● Screening tests: Gram stain, growth on BCYE and no growth on BAP or Chocolate Agar
● Serological Tests: Direct fluorescent antibody test and Indirect fluorescent antibody test
● Stains: Gram stain, Hematoxylin, Dieterle stain
● Other Tests: Colony fluorescence, β-lactamase, soluble pigment, GLC, oxidase, catalase, urease, gelatin hydrolysis, hippurate hydrolysis, nitrate reduction, ferric pyrophosphate requirement
- rapid detection can be done on urine, but only detects Legionella pneumophilia serogroup 1
● Definitive Identification:
1) DFA staining of isolates
2) GLC profiles
3) DNA hybridization (Genetic Probes)
d) Susceptibility Testing / Treatment
● In vitro susceptibility testing results are not predictive of clinical response
● Erythromycin is the drug of choice
- Azithromycin and fluoroquinolones are very effective
● High-dose trimethoprim/sulfamethoxazole and tetracyclines have been used in some patients
● Rifampin + erythromycin can be used in severe cases
GENERAL CHARACTERISTICS OF THE FAMILY
● Thin, faintly staining Gram negative bacilli
● Requirement for iron and cysteine in artificial media
● Strict pH control necessary for growth in vitro (pH 6.9 - 7.0)
● Branched chain fatty acids found in the cell wall
● Normally motile by means of a single subpolar flagellum
● Urease negative, catalase positive, nitrate negative, gelatin positive (API)
● Colonial morphology: grey-white colonies with a textured "cut glass"(CYE)
NOMENCLATURE UPDATE (42 species have been characterized)
Species Isolated from Humans
1. L. pneumophila (15); 2. L. micdadei; 3. L. bozemanii (2); 4. L. dumoffii; 5. L. feelei (2); 6. L. gormanii; 7. L. hackeliae (2); 8. L. longbeachae (2); 9. L. oakridgensis; 10. L. wadsworthii
Species Isolated from Environmental Sources only
11. L. cherrii; 12. L. erythra; 13. L gratiana; 14. L. jamestowniensis; 15. L. brunensis; 15. L. fairfieldensis; 16. L. santicrucis
Other characterized and named Legionella spp. include;
16. L. moravica 24. L. steigerwaltii
18. L. quinlivanii (2) 25. L. tucsonensis
19. L. adelaidensis 26. L. birminghamensis
20. L spiritensis (2) 27. L. rubrilucens
21. L. jordanis 28. L cincinnatiensis
22. L. anisa 29. L. israelensis
23. L. sainthelensi (2) 30. L. shakespearei





Mycoplasma and Ureaplasma
INTRODUCTION
● Small size, pleomorphic, flexible
● Do not have a cell wall
● Requirement for cholesterol for membrane function & growth
● Can replicate in a cell-free environment
● Very small genome: displaying genetic economy that requires a strict dependence on the host for nutrients and refuge.
-- smallest known free-living organisms
● Uses UGA codon for tryptophane
● Pathogenic Mycoplasmas possess extraordinary specialized tip organelles that mediate their interaction with eukaryotic cells
- Prokaryotic, 120-250 nm, with both RNA and DNA
● Some strains can survive intracellularly
- no DNA homology c known bacteria
- low guanine and cytosine content
- genome has low molecular weight
- no reversion to walled forms
- colonies morphologically similar to L-forms
● Virulence factors not well understood
● Resistant to penicillin
● Inhibited by specific Ab and certain antibiotics
CLASSIFICATION
MYCOPLASMA SPECIES OF HUMANS
1. Acholeplasma laidlawii 8. M. orale
2. Mycoplasma buccale 9. M. penetrans
3. M. faucium 10. M. pirum
4. M. fermentans 11. M. pneumoniae
5. M. genitalium 12. M. salivarium
6. M. hominis 13. M. spermatophilum
7. M. lipophilum 14. Ureaplasma urealyticum
LABORATORY DIAGNOSIS
COLLECTION, TRANSPORT, AND STORAGE OF SPECIMENS
● All specimens should be immediately set up on appropriate culture
media or placed in transport media.
CULTURE
● Special media is required (peptone base, horse serum and yeast extract)
● May take several weeks for colonies to appear
● Three colony types can be observed
1. Fried-egg colonies
2. Evenly granular type colonies
3. T-strain colonies (Ureaplasma)
GROWTH INHIBITION TESTS
● Inhibition by specific antibodies
COLD AGGLUTININ TESTS
● Non-specific, suggestive of Primary Atypical Pneumonia (PAP)
- cold agglutination tites sometimes requested in suspected cases of PAP, Abs to I Ags seen in ~1/2 pts c PAP
-- I Ag seen on almost all adult RBCs and cause agglutination of adult RBCs at 4 C but not 37 C
SEROLOGICAL TESTING PROCEDURES
● Patients with invasive M. pneumoniae or M. hominis infections will seroconvert or demonstrate a significant rise in titer.
● Response can be measured by metabolic inhibition assay, complement fixation, or ELISA
MYCOTRIM MEDIA
● More rapid growth; solid phase and liquid phase
● Mycotrim RS for respiratory samples
● Mycotrim GU for genitourinary samples
● Commercially prepared, easy to use and interpret
● Antibiotic disks are added just prior to use
● Media in flasks changes color if Mycoplasma or Ureaplasma present
● Used in conjunction with Diene's Stain
MYCOPLASMA PNEUMONIAE
Cause community acquired pneumonia nd URTIs and other airway disorders such as tracheobronchitis and pharyngitis
- Also assoc c hematopoietic, joint, CNS, liver, pancreas and cardiovascular syndromes
● World wide distribution, transmission via aerosol droplets
● Infection usually considered endemic, true epidemics are rare
● Increased incidence during winter months
● Most infections are asymptomatic (3-10% develop into pneumonia)
● Responsible for at least 65% of cases of Primary Atypical Pneumonia, also referred to as Walking pneumonia
Dx: May be able to isolate M. pneumonia on SP-4
- hold medium for 4 wks, and examine plt every 1-3 d
Sx of Primary Atypical Pneumonia
● Incubation period = 2-3 wks., gradual onset
● Fever, throbbing headache, persist non-productive hacking cough
● Sputum: microscopic & culture = "usual flora"
● Treatment instituted on basis of clinical impression
Tx: Erythromycin & Tetracycline have been used effectively
UREAPLASMA UREALYTICUM
● Previously known as T-strain Mycoplasma
● May be spread venereally, causes nongonococcal urethritis
● May be present in 50% of sexually active adults
● Usually found in association with M. hominis
● Isolation rate directly correlates with number of sexual partners
● May play a role in low birth weight, prematurity, spontaneous abortion, stillbirths, and infertility
● Urethral swabs are better specimens than are urine cultures
● Transmitted from mothers to infants
● Neonatal Infections; pneumonia, chronic lung disease, meningitis
● Infantile pneumonia, meningitis, and urinary tract infections
● Bacteremia, abcesses, arthritis in immunosuppressed patients
Mycoplasma hominis type 1
● Implicated in pharyngitis & pneumonia
● Possible role in Pelvic Inflammatory Disease
● Urinary Tract Infections
● Amnionitis and postpartum infections
● Pneumonia, meningitis, and bacteremia in newborns
● Also bacteremia, sternal wound infections, abcesses and arthritis in immunosuppressed patients
Acholeplasma
● Isolated from burns and throat swabs
● Similar to Mycoplasma but do not require cholesterol for growth
- Acholeplasma laidlawii
● respiratory distress in an infant
● seen only in animals before
- Acholeplasma oculi
● isolated in pure culture from amnionic fluid
● seen only in animals before
Mycoplasma fermentans (incognitus)
● A commensal in human mucosal tissues
● Pneumonia in otherwise healthy persons
● Disseminated disease in AIDS patients
● May be associated with numerous disease syndromes either alone or by acting as a cofactor
Mycoplasma genitalium
● Originally isolated from patients with nongonococcal urethritis
● Found in oropharynx and urethra
● More common in male homosexuals
● Implicated in pneumonia, urethritis, and Pelvic Inflammatory Disease
● Definitive proof of etiology is lacking
UNUSUAL ASPECTS OF VARIOUS MYCOPLASMAS
-Mycoplasma fermentans, M. Pirum, M. Hominis, and M. Penetrans have been proposed as human pathogens and possible cofactors in HIV infection
● May contribute to the variation in the time from infection with HIV and development of AIDS symptoms
● M. fermentans acts synergistically with HIV to enhance cytopathic effects on CD4 lymphocytes
● M. penetrans is isolated almost exclusively from urine of HIV-infected patients
● High prevalence of Abs to M. penetrans seen only in HIV-infected individuals
● M. genitalium and M. pirum also implicated as cofactors in AIDS
Malignant Transformation of cell lines used in research laboratories
● Mycoplasma infected cell lines are associated with chromosomal aberrations, altered morphologies, and cell transformation
● These oncogenic traits continue even after eradication of the infecting Mycoplasma organisms
Gulf War Syndrome
● Symptoms: chronic fatigue, joint pain, headaches, skin rashes
● About 1/3 of patients have evidence of the M. fermentans genome In blood samples
● Prolonged antibiotic treatment seems to alleviate symptoms
● There is disagreement as to whether the syndrome has an infectious etiology
Crohn’s Disease
● Respiratory infection with M. pneumoniae may exacerbate symptoms of Crohn’s disease and other chronic inflammatory bowel diseases
● Acute onset gastrointestinal symptoms are accompanied by seroconversion to specific M. pneumoniae Ags
Rheumatoid Arthritis and Other Human Arthritides
● Various Mycoplasma & Ureaplasma species are often isolated from joint tissues of patients with rheumatoid arthritis
● M. fermentans genome is found in 40% of patients in synovial biopsy specimens and in 21% of joints of patients with rheumatoid arthritis
● M. fermentans is not found in patients with reactive arthritis, chronic juvenile arthritis, osteoarthritis or gouty arthritis
Chronic Fatigue Syndrome
● M. fermentans may act as a cofactor in chronic fatigue syndrome
● It probably affects the induction of cytokines, and other immune abnormalities found in chronic fatigue syndrome
Association with Animal Mycoplasmas
● M. felis, a Mycoplasma found in cats was isolated from a patient with septic arthritis who was bitten by a cat 6 months prior to onset of symptoms
● M. edwardii, a canine Mycoplasma, was isolated from an AIDS patient in a case of fatal septicemia
● M. Arginini, a common animal Mycoplasma, was isolated from blood and multiple tissue sites from a slaughter house employee with non-Hodgkin lymphoma
L forms
"Cell-wall deficient" bacterua that grow as spheroplasts or protoplasts and can differentiate into 4 types based on ability to revert to the parental cell-walled form and the extent of cell-wall modification
- Protoplasts have cell wall entirely removed
- spheroplasts have cell wall only partially removed
Mycoplasm fried egg colonies

Biochemical tests

Mycoplasma pneumonia

Ureaplasma urealyticum

Capnocytophaga
- Gram negative fusiform-shaped bacilli, c cne end tapered, one end rounded
DF-1 Group:
- C. gingivalis, C. ochracea, C. sputigena
- Usual oral flora in humans
DF-2 Group
- C. canimorsus, C. cynodegmi
- Normally found in animals (dog mouth)
Sx - Human strains associated with periodontal disease, can see sepsis or systemic infection
- Osteomyelitis, septic arthritis, endocarditis, soft tissue inf.
- DF-2 strains: septicemia or meningitis following dog bites
Dx: Capnophilic, facultatively anaerobic, slender Gram neg. rods
- Most display gliding motility
- Grow under increased CO2 or anaerobically
- Serum can be added to CHO broths
DF-1 Group: Catalase neg. Oxidase neg. usually ARG neg.
DF-2 Group: Catalase pos. Oxidase pos. ARG pos.
All strains: Glucose pos. URE neg. LYS neg.
- Anaerobe ID systems will usually identify Capnocytophaga
DF-3 is Catalase, Oxidase, and Nitrate negative. indol positive
Cardiobacterium hominis
- Only one species in the genus
- Usual oral flora in man
- Pleomorphic rod-shaped cells with bulbous ends
- Frequently appear in clusters resembling rosettes
Sx: C. hominis is considered non-invasive
- An etiologic agent of endocarditis and abdominal abcesses
- Incidence of bacteremia is increasing
- Most patients have prior valvular disease
Dx: One of the few capnophilic, non-motile unusual Gram negative rods that are Oxidase pos. but Catalase neg.
- All strains ferment Glucose and Maltose but not Lactose or Xylose
- All are INDOL Positive but the reaction is weak
- Urease and Nitrate are negative.
Simonsiella
Family Neisseriaceae
- Usual oral flora of mammals & other warm blooded animals
- Bizarre morphology: resemble fat caterpillars
Sx: Pathogenicity is uncertain seen in neonates' gastric aspirate
Dx: Grows well aerobically on BAP
- Oxidase and Catalase positive
- ID can be made on basis of Gram Stain morphology alone
- Cells arranged side by side, tightly packed, forming a larger structure
Dermatophilus congolensis
- Genus contains only one species
- Gram positive organism (miscellaneous aerobic Actinomycete)
- Occurs worldwide in domestic animals & humans
- Forms filaments that divide longitudinally & transversely finally becoming aggregates of motile coccoid shaped spores
Sx: Etiologic agent of dermatophilosis (Strawberry foot rot, lumpy wool, mycotic dermatitis, streptotrichosis)
- Acute or chronic development of an exudative, scabbing dermatitis
- Manifestations more severe in tropical areas
Dx: Biopsy material, touch preps from the underside of scabs
- Can also culture aspirates from unopened pustules
- Colonies are at first grey then later become orange
- Colonies may be heaped, rough, glabrous, later may become mucoid
- β-hemolysis, pitting, adherence to media
- Gram Positive but Gram stain does not demonstrate the fine structure.
- Direct wet prep: filaments that branch a right angles
- Cellular morphology is characteristic but biochemical reactions may aid in identification
- Catalase pos. URE pos. IND neg. Nit neg. VP neg.
Dysgonomonas
- Small Gram negative coccobacillus
- Formerly CDC Gp. DF-3 now classified as Dysgonomonas capnocytophagoides
- Uncommon clinical isolate
Sx: Isolated from stool samples
- Most isolates from patients that are immunosuppressed or had a severe underlying disease
- Chronic diarrhea to asymptomatic carrier state
- soft-tissue abcesses, decubitus ulcers, urinary tract
- Susceptible to SXT, rifampin, chloramphenicol, tetracycline
Dx: Can be isolated from stools on Campylobacter media
- Slow growing → 24hrs. / pinpoint colonies, smooth gray-white colonies at 48-72 hrs.
- Non-hemolytic, some make “sweet” odor
- Positive Rxns: Indol, Esculin
- Negative Rxns: Oxidase, Catalase, Nitrate, Urease, Decarboxylases
- Glucose, Xylose, and Maltose fermented (Mannitol negative)
CDC GPS. EF-4a and EF-4b
Infrequently seen Gram negative coccobacillus
- Now classified with the Neisseriaceae
- EF = “Eugonic Fermenter”
- Normal oral flora of cats & dogs where they may cause purulent cutaneous infections as well as pulmonary infections
Sx: EF-4 has been isolated from human wounds from bites / scratches from cats and dogs
- Sometimes coisolated with P. multocida
Dx: Grows on BAP and Chocolate agars
- Some strains grow on MacConkey agar as well
- Certain strains have a distinct “popcorn-like” odor
- EF-4 organisms are non-motile, oxidase, catalase, and nitrate positive and negative for urease and indol
- EF-4a → Arginine positive & gelatin variable, glucose only is fermented
- EF-4b → Arginine negative & gelatin negative, glucose only is utilized Oxidatively
- Most EF-4 isolates are susceptible to a wide variety of antimicrobial agents
Capnocytophaga c "gliding" growth at fringes

Simonsiella


Dermatophilus congolensis


Misc Non-Fermenters
Acinetobacter
A. baumannii (aka Saccharolytic Acinetobacter)
A Iwoffi (aka asacharolytic Acinetobacter)
Opportunists; A. baumannii is MC isolated
- Compromised patients, usual skin flora, G.I. Tract, respiratory tract, mixed cultures, nosocomial infections, etc.; low virulence
- Oxidase negative, non-motile, Mac+, nitrate negative
- May appear as Gram negative diplococci
- May appear as Gram positive cocci when stains are made directly from clinical material or from blood culture bottles
A. baumannii
Nonmotile, non-lactose-fermentative glucose oxidizer, oxidase neg and nonhemolytic; pink colonies on MAC agar
- causes vent-assoc pneumonia, bacteremia, wound infx, UTI, meningitis in hospital (can survive for weeks) - devotes a lot of its genes to pathogenicity
- Highly resistant to abx (carbapenem)
- outer membrane protein 38 (omp38) forms biofilms
*** CRABS - Carbapenem Resistent A Baumanii **
A. lwoffi is a glucose non-oxidizer and non hemolytic
A. haemolyticus is β-hemolytic and can be either a glucose oxidizer or non-oxidizer
- A. baumannii is the second or third most commonly isolated non-fermenter in the clinical lab
- Isolates may be reported as “Acinetobacter calcoaceticus-A. baumannii complex”
- May also use the designations ”saccharolytic Acinetobacter” or “nonsaccharolytic Acinetobacter”
Chryseobacterium meningosepticum
- now known as Elizabethkingia meningoseptica
MC isolate & most important
- High virulence causing meningitis and death in infants in hospital nurseries and NICUs
- Glu oxidizer, Oxidase +, Mac +, Non-motile, YELLOW PIGMENT, INDOL +
Empedobacter brevis
- Questionable significance, pale yellow pigment, URE negative
Myroides spp
- Formerly Flavobacterium odoratum
- UTI , strong odor, yellow pigment, mucoid, sticky, spreading colonies
Weeksella virosa
- formerly CDC Gp.IIf, Indol positive, urease neg
- tan mucoid colonies
- isolated from cervical cultures
Bergeyella zoohelcum
- formerly CDC Gp.IIj, Indol positive, urease positive (rapid)
- isolated from dog and cat bites
Moraxella spp
- All are OXIDASE +, non-oxidizers, non-motile, and inactive in OF Glucose
Moraxella lacunata
- Eye infections, URT, serum required for growth, pits on the surface of plating media
Moraxella nonliquefaciens
- Respiratory infections (pneumonia, lung abcesses)
Moraxella osloensis
- G.U. Tract, URT, Blood, CSF, grows on TM, can look like G.C.
Moraxella phenylpyruvica (CDC Gp. M2)
- Urine, blood, CSF, urethra, vagina, Phenylalanine deaminase positive
Moraxella atlantae (CDC Gp. M3)
- Blood isolates, CSF
Other Moraxella-like organisms
1. Oligella urethralis Urine & genital tract
2. Neisseria weaveri (CDC Gp. M5) - Dog bites, Neisseria morphology
3. Neisseria elongata (CDC Gp. M6) Respiratory tract isolates
Eikenella corrodens
Usual flora of mucous membranes, mixed infections of head, neck, and abdominal areas, most isolates from respiratory specimens
Dx: Oxidase +, non-oxidizer, Mac negative, nitrate +, pale yellow pigment, bleach-like odor & pitting of media (noteworthy...)
Alcaligenes spp
Alcaligenes faecalis
MC isolate, normal skin flora, nosocomial infections obligate aerobe, peritrichous flagella, non-oxidizer, oxidase positive
- Al. odorans is a subgroup of Alcaligenes faecalis
Achromobacter xylosoxidans ss. xylosoxidans
- Two subspecies; ss. denitrificans & ss. xylosoxidans
- denitrificans is a non-oxidizer, xylosoxidans is an oxidizer
- Oxidase positive, non-oxidizer, Mac +, peritrichously flagellated
Other Alcaligenes-like organisms
1. Oligella ureolytica. (CDC Gp. IVe) immediate hydrolysis of urea
2. Ochrobactrum anthropi. (CDC Gp. Vd) rapid urea hydrolysis
- Blood, urine, wound cultures
Acinetobacter, gram stain

A baumanni (Saccharolytic Acinetobacter) grows well on BAP

Eikenella corrodens
Eikenella corrodens - pinpoint colonies on BAP


Bioterrorism
- terrorist attack against U.S. c biological weapons is probable
- Lab Response: Awareness of potential agents, Isolation and Identification procedures, Precautions when handling such agents, Notify authorities
Classification of Biological Weapons
Agents are classified in terms of the severity of health risk as well as ease of use in deployment as a biological weapon
- Category A - being most likely to be weaponized and pose the highest potential health risk to the greatest number of people
- Category B - less easy to disseminate and are likely to cause only moderate morbidity and low mortality
- Category C - emerging pathogens that have the potential for mass dissemination
Biological agents: Bacteria, Protozoa, Rickettsia, Viruses, Fungi
Toxins: Biological toxins, Poison gas, Chemicals
Potential sx:
1. Acute respiratory paralysis
2. Central nervous system disorders
3. Organ failure leading to death as final outcome
Anthrax
Category A agent: Bacillus anthracis
- normal animal dz
- Infectious form: Spores
-- edema factor is an adenylate cyclase
- Diagnostic Features of inhalation anthrax: Incubation period 1-6 days, fever, malaise, cough, chest pain, severe respiratory distress, shock
- possibly death in 24-36 hrs. after initial symptoms
- GI and cutaneous forms not lethal
Dx: blood culture or Gram stain of peripheral blood
- usually comes late in disease
Tx: high dose Ciprofloxacin, Doxycycline, Penicillin
Brucellosis
Category B agent, Brucella spp. (B. abortus, B. suis, B. melitensis)
- Highly infectious
Dx:: 5-60 day incubation period - can be shortened
with large aerosol doses, incapacitating disease but low mortality (<5%)
- normally in unpasteurized dairy
DX: nonspecific febrile illness, headache, myalgia, arthralgia, back pain, sweats, chills, malaise (5% develop meningitis)
Tx: Doxycycline + Rifampin for 6 wks.
Cholera
Vibrio cholera, rarely P2P transmission, low risk
- enterotoxin production, transmitted in H20
Dx: Rice water stools, diarrhea with extreme fluid loss leading to dehydration
- Motile vibrios in stools / biochemical identification in laboratory
Tx:; restoration of fluid & electrolyte balance, antibiotics will reduce shedding of organism
Glanders
Category B agent: Burkholderia mallei
- Burkholderia pseudomallei in SE Asia, called melioidosis
- Normally dz of horses, but can cause disease in humans by inhalation or cracks or sores in skin
- extremely infectious in lab
- 4 forms of infx
1. Acute localized (cutaneous or mucosal)
2. Septicemia
3. Acute pulmonary
4. Chronic cutaneous
Sx: Cutaneous form: nodules & ulcerations.
- Systemic: papular or pustular rash resembling smallpox
- Clinical presentation (septicemic): sudden onset fever, rigors, sweats, myalgia, chest pain, photophobia, lacrimation, diarrhea
- Mucosal form: oral, nasal, conjunctival mucosa blood-streaked discharge from nose
- All forms can cause acute septicemia
Dx: Gram stain of exudates & routine culture
Tx: need susceptibility testing
- high mortality despite antibiotic treatment
The Plague
- Category A agent: Yersinia pestis
- Pneumonic form of disease is best suited as biological weapon
Dx: (pneumonic plague): malaise, high fever, chills, headache, myalgia, cough with bloody sputum and toxemia
- bronchopneumonia, dyspnea, strider, cyanosis
- respiratory failure, circulatory collapse, bleeding diathesis can cause death
- 2-3 day incubation period
Dx: Gram stain lymph node aspirate, sputum, CSF
- definitive diagnosis by culture
Tx: 72 hr. isolation (Streptomycin, tetracycline, chloramphenicol, gentamicin, ceftriaxone)
- Vaccine is available, doxycycline can be given prophylacitcally
Tularemia
Category A agent: Franciscella tularensis
- 3 forms
1. Ulceroglandular
2. Septicemic
3. Pneumonic
- Septicemic form a bioterrorist attack
- Occurs after respiratory, intradermal, or gastric inoculation
- Pneumonic tularemia primary (inhaled bacteria) or secondary (produced after patient is septic)
- Acute onset, 2-10 days after exposure
Sx: nonspecific; diagnosis diffcult , direct Gram stains usually negative
- grows poorly on conventional media
Tx: intramuscular streptomycin for 10-14 days (Gentamicin)
Q-fever
Category B agent: Coxiella burnetii
- normally in sheep, cattle, goats
- aerosol route extremely infective
- incubation period 10-20 days, dz self-limiting, lasts from several days to two wks.
Sx: headache, myalgia, fatigue, 1/2 get pneumonia
Tx: Tetracycline or doxycycline shorten duration
- Vaccine available, antibiotics can be prophylaxis
VIRI
Venezuelan Equine Encephalitis
Category B agent: Venezuelan Equine Encephalitis virus (VEE)
- usually in horses, carried by mosquitoes
- Wet & dry forms are stable and can be released by aerosol or through water or food contamination
- VEE causes inflammation of meninges & brain / fatalities <1%
- dz acute and short-lived, incubation period 1-5 days
Sx: malaise, fever, rigors, severe headache, photophobia, myalgia of legs and lower back
- Secondary sx: nausea, vomiting, diarrhea, cough, pharyngitis
Tx: control sx, No vaccine available
Viral Hemorrhagic Fevers
Category A agents: RNA viruses, several virus groups
- Filoviridae (Ebola & Marburg)
- Arenaviridae (Lassa fever, Argentine & Bolivian hemorrhagic fevers)
- Bunyaviridae (Hantavirus, Congo-Crimean hemorrhagic fever, Rift Valley fever, Yellow fever)
- Dengue hemorrhagic fever, and others
- Aerosolized biological weapons do not exist for some of these viruses
- These agents target the vascular system
Sx: fever, myalgia, hypotension, flushing, petechiae
- quickly leads to shock and generalized mucous membrane hemorrhage
- Kidney failure and cardiovascular decline cause mortality rate 5-20% or higher (Ebola 50-90% fatality)
Dx: detailed history of patient is important large # cases in a nonendemic area suspicious of a bioterrorist action
- sx can resemble typhoid, rickettsial infection, relapsing fever, leptospirosus
- Serological testing is available for some
Tx: supportive
Smallpox
Category A: Smallpox virus, an orthopoxvirus
- 2 major forms variola major and variola minor
- Highly infectious if aerosol, easy to make, and the no immunity (ideal biological weapon)
- Incubation period 12 days (patients and contacts quarantined until 16 days after exposure)
Sx: malaise, fever, rigors, vomiting, headache, backache
- 48-72 hrs. later rash on face, hands, extremities (centrifugal distributionn)
- 2 wks. after onset, pustules form scabs that become depressed and depigmented, then forms scar
-- pts infectious until all scabs disappear
- Variola major can cause up to 30% mortality among unvaccinated
- Early stages of disease indistinguishable from chickenpox
Dx: Clinical picture + E.M. studies from vesicular scrapings
- Confirmed case = international health emergency
- No effective antiviral drugs available
Botulinum toxin
- Clostridium botulinum makes A to G toxins, that can all cause sx
- can be aerosolized and inhalation causes botulism
- causes paralysis from neurotransmission block
- less than one day to see sx
Sx:blurred vision, diplopia, photophobia, dysarthria, dysphagia, and dysphonia
- Later, symmetrical descending progressive weakness that can result in respiratory failure
- can be confused with other conditions
Dx: Lab testing usually not helpful
- Antitoxin available from CDC and a toxoid has been used for those considered at high risk for inhalation of botulinum toxin
Staphylococcal Enterotoxin B
Category B: toxin produced by Staphylococcus aureus that normally causes food poisoning
- could possibly be aerosolized
- dz different inhaled vs ingestion
- Mortality low but incapacitating
Sx: initially, fever, headache, chills, myalgias, nonproductive cough
- Later; nausea, vomiting, and diarrhea cause high fluid loss
- Fever 103-106"F up to 5 days
- Severe cases may develop pulmonary edema and acute respiratory distress syndrome
- Lab testing not helpful: symptoms similar to a variety of other infections
Tx: supportive care, no vaccine available
Ricin
Category B agent: toxin derived from castor beans
- easy and inexpensive to produce
- Toxicity to cells due to inhibition of protein synthesis
- amt toxin inhaled determines dz severity
Sx: fever, chest tightness, cough, dyspnea, nausea and arthralgias within 4-8 hrs. of exposure
- If large dose inhaled, severe airway and alveoli causing death in 18-72 hrs.
- Ingestion of Ricin produces gastrointestinal hemorrhage, and necrosis of liver, spleen, and kidneys
Dx: sx nonspecific and dx in aerosol attack would be based on clinical & epidemiological data
Tx: supportive, no vaccine available
T-2 TOXINS
Category B: trichothecene mycotoxins
made by filamentous fungi including Fusarium, Myrotecium, Trichoderma, Stachybotrys
- If ingested: produce a lethal illness called alimentary toxic aleukia (ATA)
Sx: abdominal pain, diarrhea, vomiting, prostration
- progresses to fever, chills, myalgias, and bone marrow depression causing granulocytopenia and sepsis
- If patient survives this stage, the illness progresses to painful pharyngeal & laryngeal ulceration and diffuse bleeding into the skin
- Concurrently, other symptoms present; bloody diarrhea, hematuria, hematemesis, epistaxis and vaginal bleeding
- T-2 toxins can enter through skin, stomach, or lungs
- Skin: burning, redness, blistering, skin necrosis
- Nasal mucosa: nasal pain, sneezing, rhinorrhea, dyspnea, wheezing, cough, bloody saliva and sputum
- Eyes: eye pain, tearing, redness, blurred vision
- Systemic intoxication: weakness, prostration, dizziness, ataxia, loss of coordination
- Death can occur in minutes, hours, or days
- No lab tests available / no treatment
- Gas masks & protective chemical gear to prevent exposure

mass spec of bacillus spore

Glanders

Tularemia ulcer


Q fever

Smallpox rash



References
1. The U notes
